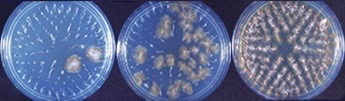

- アトピー性皮膚炎は、増悪・寛解(症状が一時的あるいは継続的に軽減した状態)を繰り返す、掻痒のある湿疹を主病変とする疾患であり、患者さんの多くはアトピー素因を持つと定義されています。
- アトピー素因とは、家族歴・既往歴に気管支喘息、アレルギー性鼻炎・結膜炎、アトピー性皮膚炎のいずれか、あるいは複数の疾患を有する、またはIgE抗体を産生し易い素因と定義されます。
- <アトピー性皮膚炎の診断基準:(1)〜(3)>
- (1)掻痒(痒み)
- (2)特徴的皮疹と分布:(a)(b)
- (a)皮疹は湿疹病変
- 急性病変(湿疹三角の全て):紅斑(赤み)、湿潤性紅斑(ジクジクしている赤み)、丘疹(ブツブツ)、漿液性丘疹(比較的さらさらした透明な分泌液を有するブツブツ)、鱗屑(かわむけ)、痂皮(かさぶた)
- 慢性病変:浸潤性紅斑(まわりに広がっていく赤み)・苔癬化病変(炎症が繰り返されて皮膚が肥厚した状態)、痒疹(痒みの強いブツブツ)、鱗屑、痂皮
- (b)分布:左右対側性で、好発部位は前額部、眼囲、口囲・口唇、耳介周囲、頸部、四肢関節部、体幹です。
- 参考となる年齢による特徴
- 乳児期:頭、顔にはじまりしばしば体幹、四肢に下降
- 幼小児期:頸部、四肢関節部
- 思春期・成人期:上半身に皮疹が強い傾向
- (3)慢性・反復性経過:乳児では2ヶ月以上、その他では6ヶ月以上を慢性とします。
- 上記(1)〜(3)全て満たすものをアトピー性皮膚炎と診断します。
- その他は急性湿疹、慢性湿疹とし、年齢や経過を参考にして診断します。
- なおアトピー性皮膚炎と診断する前に除外する疾患が多くあります。
- 診断の参考項目として、アトピー素因と毛孔一致性の丘疹による鳥肌様皮膚があります。
<臨床型>
四肢屈側型、四肢伸側型、小児乾燥型、成人に多い上半身型、痒疹型、全身型、これらを混在する症例が多い
<合併症>
伝染性膿痂疹(とびひ)、伝染性軟属腫(みずいぼ)、カポジ水痘様発疹症
眼病変(白内障、網膜剥離など)
- <重症度分類>
- 重症度を点数化し評価することは、診療時間の制約により困難な場合があります。
- 簡便な方法として、厚生労働科学研究班により重症度の目安が提案されています。
軽症:面積に関わらず、軽度の皮疹のみみられる
中等症:強い炎症を伴う皮疹が体表面積の10%未満にみられる
重症:強い炎症を伴う皮疹が体表面積の10%以上、30%未満にみられる
最重症:強い炎症を伴う皮疹が体表面積の30%以上にみられる
軽度の皮疹とは、軽度の紅斑、乾燥、落屑主体の病変です
強い炎症を伴う皮疹とは、紅斑、丘疹、びらん、浸潤、苔癬化などを伴う病変です
- 以上 アトピー性皮膚炎診療ガイドラインより引用しました
- <検査>
- 末梢血好酸球数や血清LDH値(短期的病勢を反映します)
- IgE検査(RIST)
- ダニ、ハウスダスト、花粉、真菌、動物の上皮、食物などに対する特異的IgE検査(RAST)測定
- ヒトTARC定量(アトピー性皮膚炎の活動性炎症の指標)
- 接触アレルゲンをパッチテストで確認
- <治療及び当院の治療方針:(1)〜(4)>
- (1)スキンケア:冬季乾燥時期は、石鹸・シャンプーの使用頻度を減らして下さい。
- (2)原因・悪化因子の除去。
- (3)薬物療法:(a)〜(f)
- (a)ステロイド外用薬:ステロイド外用薬に対する正しい知識と使用法を理解して頂きます。炎症所見の鎮静後にステロイド外用薬を中止する際には、急に中止することなく、症状をみながら漸減あるいは間欠投与を行い徐々に中止して下さい。また急性憎悪期にステロイド外用薬を使用し皮疹が軽快した後に、週に2〜3回ステロイド外用を維持するプロアクティブ療法を推奨しています。根拠のないステロイド忌避は、症状増悪の要因となります。皮疹の重症度(上記重症度分類を参照)により、ステロイド外用薬の強さの選択(ストロンゲスト〜ウィークまで5段階あり)が異なります。外用量はfinger tip unit(FTU)に従います。第二手指の先端から第一関節まで直径5mmの外用チューブを押し出した量が約0.5g(1FTU)で成人の体表面積の約2%に相当します。成人では全身に塗布するのに必要な外用量は、約25gよりやや少なめの量を目安にして下さい。
- (b)タクロリムス軟膏(商品名 プロトピック軟膏):タクロリムス軟膏に対する正しい知識と使用法を理解して頂きます(外用できない部位・皮疹あり、最初に外用、皮膚刺激感あり)。重症の皮疹には、ステロイド外用薬により皮疹の改善を図った後にタクロリムス軟膏に移行することをお勧めします。またタクロリムス軟膏にも上記プロアクティブ療法の有効性は、明らかにされています。特に安全性に対する理解と寛解維持療法を徹底して頂きます。
- (c)外用JAK阻害剤デルゴシチニブ軟膏(商品名 コレクチム軟膏):顔面・頚部の痒みと軽度の皮疹に対し、ステロイド外用薬やタクロリムス軟膏に代わる選択肢となります。特に痒みに対し有効な方は、外用部位を体幹・四肢に拡げて治療しています。2歳以上の小児から使用出来ます。また目の周りに眼科用ステロイド外用薬を使用し眼圧上昇・緑内障や白内障になるリスクを高める問題に対し、ステロイド外用薬に代わる選択肢となり得ます。
- (d)抗ヒスタミン薬:痒みに伴う苦痛の軽減と痒みによる掻破のための悪化を予防する目的で処方します。
- (e)保湿剤(ヘパリン類似物質含有製剤、尿素軟膏)、保護剤(ワセリン、亜鉛華軟膏)など。
- (f)デュピクセント皮下注、オルミエント錠・リンヴォック錠の適応患者さんは、病院皮膚科を紹介しています。
<アトピー性皮膚炎に対するステロイド外用薬を用いた外用療法の変遷>
・リアクティブ療法:従来からの方法で、炎症を鎮静化するためステロイド外用薬を連日外用、寛解導入後は炎症が再燃すればその都度ステロイド外用薬を外用します。アトピー性皮膚炎の寛解と増悪を繰り返す経過を断ち切ることは難しく、ステロイドの耐性(薬効の低下)を誘導するという課題があります。
・プロアクティブ療法:リアクティブ療法の反省を踏まえ、2008年ヨーロッパで提唱されました。寛解導入まではリアクティブ療法と同様ですが、炎症が消失した後も炎症があった部位に週に2・3回間欠的に外用していく方法です。プロアクティブ療法はリアクティブ療法に比べ、湿疹改善度・QOL、黄色ブドウ球菌の分離率、ダニ感作に関し、優位性が報告されています。ステロイド外用薬の特性と寛解維持期間に関し、医師の十分な説明の上、患者さんと家族の理解が必要です。
・寛解とは、症状が一時的あるいは継続的に軽減した状態を指します。
・全ての療法は、毎日欠かさず保湿剤を塗る事が前提です。
- (4)紫外線療法:アトピー性皮膚炎に保険適応である紫外線療法は、ナローバンドUVB療法とターゲット型エキシマライト照射療法があります。原則として、アトピー性皮膚炎にはナローバンドUVBで皮疹がない部位を含めた全身照射が望ましいと思われます。全身照射あるいは内服・外用治療で治りにくい病巣(特に苔癬化病変と痒疹)に、ターゲット型エキシマライトで追加照射するのも効果的です。勿論難治性の苔癬化病変と痒疹のみに、ターゲット型エキシマライト照射療法を行うことも出来ます。ナローバンドUVB療法とターゲット型エキシマライト照射療法は、組み合わせ治療が可能です。薬物療法で痒みと強い炎症を伴う皮疹が改善されない患者様のなかに、数回〜5回位の紫外線療法で改善させることが可能な症例があります。
- 詳細は、日本皮膚科学会アトピー性皮膚炎診療ガイドライン2024をご参照下さい。
- 接触皮膚炎は、外来の刺激物質や抗原(ハプテン)が皮膚に接触することによって発症する炎症性の湿疹反応と定義します。湿疹とは、外的・内的刺激に対する表皮・真皮上層を場とし、かゆみ、ヒリヒリ感を伴う可逆性の炎症反応です。湿疹の形成機序は、外界よりの異物(接触アレルゲン)に対する生体の異物排除機構の作動に伴い形成されるものです。
- <発症機序による分類>
- 接触皮膚炎は、発症機序により(1)刺激性接触皮膚炎(2)アレルギー性接触皮膚炎(3)光接触皮膚炎(4)全身性接触皮膚炎、接触皮膚炎症候群に分けられます。
- (1)刺激性接触皮膚炎:(a)〜(e)に分類。外来の化学物質などが角質層を破って引き起こします。
- (a)急性刺激性皮膚炎:単一かつ非常に強い刺激物質との接触で生じる皮膚障害です。
- (b)刺激反応性刺激性皮膚炎(慢性化します):美容師、調理師などに起こります。界面活性剤(洗剤、シャンプー・リンス、化粧品の乳化剤・保湿剤などに使用)、パーマネント液などが原因となります。
- (c)蓄積性刺激性皮膚炎(慢性化します):主婦や水仕事の多い方に、弱い刺激物質が繰り返し曝露することにより生じます。界面活性剤、消毒液、化粧品、エポキシ樹脂(接着剤、土木建築材料、塗料、歯科材料などに使用)などが原因となります。
- (d)膿疱性・ざ瘡性刺激性皮膚炎:油性の化学物質によりざ瘡などの毛包系の病変が生じます。塩素化合物、鉱油類、タールなどが原因となります。
- (e)機械性刺激性皮膚炎:微小損傷を繰り返し起こります。ガラスウール、ロックウールなどが原因となります。
- (2)アレルギー性接触皮膚炎:(a)〜(f)に分類。アレルゲンによる感作・惹起反応が起こって成立します。
- (a)植物・動物と接触皮膚炎:ウルシ科植物(ウルシ、カクレミノ、ハゼなど)、ギンナン、サクラソウ、キク、ランタナ、クレマチスなどが原因となります。
- (b)食物と接触皮膚炎:マンゴー(ウルシとの交差感作あり)、カシューナッツオイル、ギンナン、キク科・ユリ科・セリ科植物他、香辛料、ハーブ、プロポリスなどが原因となります。
- (c)家庭用品と接触皮膚炎:金属(コバルト、ニッケル、クロム)、染料、ゴム、抗菌剤、カシューナッツオイル(サンダル、塗料に)などが原因となります。ニッケルによるアレルギーは、ピアスなど装飾品に接触すると感作が成立します。ニッケルと歯科金属に使われるパラジウムは交差反応を示します。ピアスに伴う皮膚障害の既往がある患者さんは、何らかの金属アレルギーが有意に多く、装飾品に含まれるニッケルが将来的に歯科金属アレルギーを引き起こし易くする可能性が指摘されています。
- (d)化粧品と接触皮膚炎:化粧品に含まれる香料・保存料、ジアミン系酸化染料、口紅、ヘナ、ラノリンなどが原因となります。
- 毛染めによる皮膚障害を詳しく知りたい患者さんは、消費者庁 安全調査委員会報告書(毛染めによる皮膚障害)をご参照下さい。
- (e)外用剤と接触皮膚炎:抗菌外用薬、ステロイド外用薬、非ステロイド系外用薬、点眼薬(アミノグリコシド系抗菌薬が多い)、抗真菌薬(使用頻度の高いイミダゾール系抗真菌薬が多い)、湿布薬などが原因となります。
- (f)職業性接触皮膚炎:農業(農薬、肥料、農作物など)、工業(塗料、金属、界面活性剤、エポキシ樹脂、ゴム剤など)、美容師(界面活性剤、染毛剤、パーマネント液、ブリーチ剤など)、医療従事者(消毒剤、ゴム手袋、歯科用材料など)、事務職(デスクマット)などが原因となります。
- (3)光接触皮膚炎:アレルゲンに光線が当たり活性酸素を生じて組織障害を起こしたり、一部が光分解されることによって生じます。ケトプロフェンが有名です。
- (4)全身性接触皮膚炎、接触皮膚炎症候群
- 全身性接触皮膚炎:接触感作成立後に同一抗原が経口・吸入・注射などで侵入することにより全身に皮膚炎を生じる。金属含有食品、歯科金属、金属の粉塵の吸入、パラベン(防腐剤)、ギンナンなどが原因となります。金属含有食品や歯科金属よる全身性接触皮膚炎(全身型金属アレルギーとも呼びます)は、異汗性湿疹、亜急性痒疹、多型慢性痒疹が多く、他に掌蹠膿疱症、扁平苔癬、貨幣状湿疹、自家感作性皮膚炎、汎発性湿疹、紅皮症、Pseudo-atopic dermatitisなど、様々な形態を呈すると言われています。アトピー性皮膚炎の中にも全身型金属アレルギーを持つ患者さんがいます。全身型金属アレルギーの方は、必ずしも金属アレルゲンのパッチテストは陽性になりません。その場合、金属を含む食品(チョコレート、ココア、ナッツ、豆、貝など)を摂取制限して皮疹が改善するか、負荷して増悪するか否かを繰り返し観察して頂きます。
- 接触皮膚炎症候群:接触感作成立後に同一抗原が繰り返し経皮的に接触し、痒い湿疹病変が接触範囲を越えて全身に出現する状態。上記(2)アレルギー性接触皮膚炎を引き起こすアレルゲンは原因となる可能性があります。従来より接触皮膚炎発症後に自家感作性皮膚炎を併発する症例がありましたが、それを接触皮膚炎症候群と表現したと考えます。
- <検査>
- アレルゲンを推測してパッチテストを行います。当院では化粧品・外用薬などはオープンテストやas isでパッチテストを行っています。染毛剤、パーマ液、脱毛クリーム、揮発性製品は、オープンテストをお勧めしています。
- ジャパニーズスタンダードアレルゲンに対応する21種類のアレルゲンを含むパッチテストパネル(S)は、当院で実施出来ます。
- なお特殊な成分によるパッチテストは行っておりませんので、病院皮膚科をご紹介します。
- <治療>
- 原因物質を同定し、接触源を断つことが必須です。
- 保湿しステロイド外用薬で炎症を鎮静化させます。掻痒が強い時は、抗ヒスタミン薬の内服を併用します。
- 全身性接触皮膚炎、接触皮膚炎症候群の場合は、ステロイド外用薬と抗ヒスタミン薬内服に加え、プレドニゾロン(20mg/日)の内服が必要な場合があります。
- 金属含有食品や歯科金属による全身性接触皮膚炎(全身型金属アレルギー)の方は、アレルギーを示す金属の含有量の多い食品の摂取制限をすると有効な場合があります。パッチテスト陽性を示した金属が歯科金属に含まれていた症例では、その歯科金属を除去すると有効な場合があります。薬物療法として、クロモグリク酸ナトリウム3~6g/日・分3・毎食前内服、テトラサイクリン200mg/日内服、ノックビン内服があります。
- 詳細は、日本皮膚科学会接触皮膚炎診療ガイドライン2020をご参照下さい。
- 脂漏性皮膚炎は、日常診療でしばしば遭遇する皮膚病で皮疹の性状と分布から典型例の診断は比較的容易ですが、症例により鑑別が困難なこともあります。発症時期により、乳児脂漏性皮膚炎と成人期脂漏性皮膚炎に分類されますが、発症に連続性はありません。
- <分類>
- (1)乳児脂漏性皮膚炎:生後まもなく、乳痂(脂性の厚い痂皮)で覆われた紅斑が頭皮、顔面、おむつ部に見られます。原発疹として、毛孔一致性の紅色丘疹が同部位に見られます。予後は良好で、数ヶ月以内に軽快し、1歳位までに治癒します。
- (2)成人期脂漏性皮膚炎:頭皮、眉毛から眉間、鼻唇溝、耳介内側と後面、胸背部に好発し、時に間擦部すなわち腋窩、乳房下、臍部、股部に、脂性あるいは乾いた鱗屑が付着した黄色調の紅斑が見られます。頭皮でフケ症を訴え、体幹はしばしば長円形の紅斑局面を多発します。痒みは軽度です。病状は、寛解と増悪を繰り返し、生活習慣病と伴に慢性化する方がいます。
- <病因>
- マラセチアとの関連:マラセチアは皮膚に常在する好脂性真菌(カビ)です。抗真菌剤が脂漏性皮膚炎に有効であること、マラセチアの菌要素の量と脂漏性皮膚炎の重症度と相関することから脂漏性皮膚炎とマラセチアの関連が示唆されています。またマラセチアにより分解された皮脂の刺激や菌に対する免疫反応が炎症をもたらします。
- <診断と鑑別診断>
- 典型例の診断は、視診により比較的容易です。
- 乳児脂漏性皮膚炎と乳児期のアトピー性皮膚炎との鑑別は困難で、激しい痒み、アトピー素因、IgE高値であれば乳児期のアトピー性皮膚炎を示唆します。
- 成人期脂漏性皮膚炎の鑑別診断として、特に尋常性乾癬が挙げられます。頭部に皮疹が限局している場合は鑑別が困難ですが、銀白色の鱗屑で紅斑の境界が明瞭であれば尋常性乾癬と診断出来ます。
- 鑑別診断として前記以外に、接触皮膚炎、酒さ、頭部白癬、体幹でジベルばら色粃糠疹、間擦部でカンジダ症が挙げられます。
- HIV感染症患者に、高度な脂漏性皮膚炎を来たします。
- 抗腫瘍薬である上皮成長因子受容体阻害薬(EGFRIs)の副作用として、ざ瘡様皮疹を混じた脂漏性皮膚炎を生じることがあります。
- <治療>
- (1)乳児脂漏性皮膚炎
- 頭皮の乳痂(脂性の厚い痂皮)は、オリーブ油で30分位柔らかくしてから洗浄します。乳痂が取れるまで、繰り返し行う必要があります。
- 炎症が強い場合は、弱め(マイルドランク)のステロイド外用薬を使用します。
- (2)成人期脂漏性皮膚炎
- 問診より悪化要因を探り、生活習慣改善に努めて頂きます。
- 抗真菌成分の含有したシャンプー、泡石鹸、リキッドソープは、症状の寛解維持に有効です。
- 薬物療法として、ステロイド外用薬と抗真菌薬のケトコナゾール外用薬を使い分けます。被髪頭部にはローション剤を使用します。皮疹の炎症が強い時は、ステロイド外用薬で炎症を軽減させてから(顔面にマイルドランク、体幹にストロングランクを使用)ケトコナゾール外用薬へ徐々に切り替え維持していきます。ケトコナゾール外用薬は、ステロイド外用薬よりも外用中止後の寛解期間が長く持続し、再発予防効果が期待出来ることが報告されています。
- 加齢に伴う皮膚保湿因子の減少、乾燥する環境、そして誤ったスキンケアにより、皮膚が乾燥し(乾皮症)かゆみを伴いかきこわして湿疹化します。皮膚に炎症を起こした状態を、皮脂欠乏性皮膚炎と診断します。
- <どのような人がなりやすいか>
- 主に高齢者ですが、発症年齢に個人差があります。
- 年齢を問わず、乾燥肌や敏感肌の素因を持っている患者さん。
- 入浴時ナイロンタオルなどで体をごしごし洗う患者さん。
- <どのような時期に症状があるか>
- 10・11月以降の秋・冬から暖かくなる春まで。
- 梅雨から夏のみ症状がない方もいます。
- <好発部位>
- 特に下腿前面を中心とする下肢。
- 腰、背部など体幹。
- 体幹、四肢と全体に広がる方もいます。
- <治療>
- 乾燥肌全体に、手掌を使い入浴後と朝の1日1〜2回保湿剤を塗る。1日1回の時は入浴後に塗って下さい。
- かきこわしている部位や湿疹には1日1〜2回ステロイド外用剤を塗る。
- 強いかゆみを伴う時や湿疹が悪化している時は、抗ヒスタミン薬を服用する。
- <日常生活の注意>
- 低刺激性石鹸を使い石鹸を手で泡立てて体を手洗いする。それでも乾燥する方は、週に数回とか石鹸を使う頻度を減らす。
- 入浴は毎日してもよいが、浴槽のお湯の温度は40℃を上限に比較的ぬるめにし、長湯をしないで下さい。
- 肌着は木綿素材を選び、保温性のある化学繊維のインナーは木綿肌着の上に着て下さい。
- かきむしらないように、日頃から爪を短く切って下さい。
- かゆみが増強するような過度の飲酒や食品は控えて下さい。
- 電気毛布、エアコンなどの長時間の使用は、皮膚が乾燥しかゆみが増強するので注意して下さい。
- 加湿器で部屋の湿度を50%以上に維持する。
- 掌蹠(手のひらと足の裏)、手足指に小水疱が出現し(異汗症・汗疱と命名)、発汗が増加する夏に悪化します。湿疹病変を形成する場合に、異汗性湿疹と診断します。異汗症・汗疱の方で鱗屑(かわむけ)を中心とする場合もあります。
- 大人は喫煙者に多く見られ、タバコが悪化因子の一つと考えます。
- 足白癬(みずむし、顕微鏡で白癬菌を証明する)、掌蹠膿疱症(手のひらと足の裏に小さな黄色のうみが出没する)との鑑別が必要です。
- 歯科金属や食品に含まれる金属を、口腔粘膜や消化管より体内に吸収し発症する全身型金属アレルギーの一症状として注目されています。全身型金属アレルギーが疑われる患者さんで、金属アレルゲンのパッチテストが陰性の方は、金属を含む食品を制限して皮疹が改善するか、繰り返し摂取負荷して増悪するかを確認して頂くことがあります。
- 抗ヒスタミン薬とステロイド外用薬の通常治療で治らない方に、ターゲット型エキシマライト照射療法が奏功する症例があります。
- 手湿疹とは、手掌・手背・手指に生じる湿疹(皮膚炎)の総称です。手湿疹患者さんの7割に、アトピー素因を持つと言われています。
<発症機序による手湿疹の分類>
(1)刺激性接触皮膚炎:利き手の指先・手掌・爪囲に、乾燥・鱗屑・軽度紅斑が出現します
(2)アレルギー性接触皮膚炎:アレルゲンが接触した指先・母指球・手背側とアレルゲンが残りやすい指間や指の側面に、紅斑・小水疱が出現します
(3)アトピー型手湿疹
(4)混合型(上記発症機序が重なり合っている場合)
<形態による手湿疹の分類>
(1)角化型手湿疹
(2)再発性水疱型手湿疹(いわゆる異汗性湿疹)
(3)進行性指掌角皮症
(4)貨幣状湿疹
(5)乾燥・亀裂型手湿疹
<手の職業性接触皮膚炎>
(1)農工業従事者に、酸・アルカリ・フッ化水素・セメント・灯油で起こる急性の刺激性接触皮膚炎(化学熱傷)
(2)美容師・調理師に、化学物質・樹脂・界面活性剤・消毒剤・化粧品で起こる慢性の刺激性接触皮膚炎(主婦湿疹)
(3)美容師・理容師に、染毛剤に含まれる化学物質で起こるアレルギー性接触皮膚炎
(4)医療従事者に、ゴム・化学物質で起こるアレルギー性接触皮膚炎
(5)生花店員・農業従事者に、植物・食物で起こるアレルギー性接触皮膚炎
- <診断と検査>
- 職業・職場環境や生活習慣について問診より個人情報の収集を行います。その後 手・前腕部の皮膚所見を見て、刺激性接触皮膚炎あるいはアレルギー性接触皮膚炎なのかを見極めます。
- ステロイド外用薬で痒み・湿疹が改善しない、またはアトピー性皮膚炎があり治療により改善しない患者さんは、アレルギー性接触皮膚炎を疑います。
- アレルギー性接触皮膚炎を疑ったら、アレルゲンを推測してパッチテストを行います。ジャパニーズスタンダードアレルゲンに対応する21種類のアレルゲンを含むパッチテストパネル(S)は当院で行っています。
- 化粧品・外用薬などは、オープンテストやas isでパッチテストを行っています。染毛剤・パーマ液・脱毛クリーム・揮発性製品は、オープンテストをお勧めしています。
- なお特殊な成分によるパッチテストは行っておりませんので、病院皮膚科をご紹介します。
- <治療>
- 原因物質の除去。
- 手湿疹の患者さんは、皮膚のバリア機能が低下しているので、保湿剤を両手全体に1FTU(人差し指の先から第一関節までの長さ)分の外用量を、決められた回数塗るのではなく、手が潤っている状態を維持することを目的に頻回に塗って下さい。
- 痒い炎症性皮疹は、very strongクラスのステロイド外用薬で速やかに治します。
- 角化型手湿疹は、尿素軟膏とステロイド外用薬を併用します。
- 進行性指掌角皮症は、保湿剤が中心となります。
- 当院では、掻破・剥離・亀裂を伴う手湿疹の患者さんには、10%亜鉛華軟膏を用いる重層法(ぬりはり)を指導しています。
- 蕁麻疹は、膨疹すなわち紅斑を伴う一過性・限局性の浮腫が病的に出没する疾患です。多くは痒みを伴い、膨疹は24時間以内に出没します。
(1)特発性蕁麻疹
(2)刺激誘発型蕁麻疹:(a)〜(g)の7つに分類、(e)物理性蕁麻疹は物理的刺激によりさらに細分化されています
(3)血管性浮腫
(4)蕁麻疹関連疾患
(1)特発性蕁麻疹:原因不明で、蕁麻疹の2/3以上がこのタイプです。発症して1ヶ月以内が急性蕁麻疹、1ヶ月以上経過したものは慢性蕁麻疹と呼びます。急性蕁麻疹のなかには、細菌、真菌、ウイルス、マイコプラズマなどの感染症が原因となるものがあります(急性感染症蕁麻疹)。慢性蕁麻疹のなかには心身医学的治療が必要な治療抵抗性蕁麻疹があります。
(2)刺激誘発型蕁麻疹:(a)〜(g)の7つに分類
(a) アレルギー性蕁麻疹:抗原(食物・薬剤・天然ゴムを含む植物・昆虫の毒素など)が体内に入り1時間以内に発症します。全体の1割以下。アナフィラキシーショック、口腔アレルギー症候群(野菜・果物が原因)もこのタイプです。
(b) 食物依存性運動誘発アナフィラキシー(FDEIA):食物摂取に加えて運動することで発症します。日本では、FDEIAの原因食物の約60%が小麦(主要抗原は、約80%ω-5グリアジン、 約20%グルテニン)で、エビ、イカ、カニの順となっています。(通常小麦型FDEIA)加水分解コムギ型FDEIAは、加水分解コムギ(グルテンを酵素や酸で処理したもの、乳化性や保湿性を持つため化粧品の添加物として使用)を含有した石鹸に経皮または経粘膜的に感作され、後に経口摂取した小麦蛋白との交差反応によってFDEIAを発症したものと考えられています。加水分解コムギを含有した石鹸の使用開始からFDEIA発症までの期間は、概ね数ヶ月から数年で、症状の特徴は小麦摂取後の運動時の眼瞼浮腫です。小麦とグルテン特異的IgE陽性率は通常小麦型FDEIAより高く、 ω-5グリアジン特異的IgE陽性率は通常小麦型FDEIAより低い傾向にあります。
(c) 非アレルギー性蕁麻疹:造影剤の静脈注射、ヒスタミン含有食品(豚肉・サバ・タケノコなど)、食品添加物(防腐剤・人工色素)、サリチル酸などが原因です。
(d) アスピリン蕁麻疹:非ステロイド系抗炎症薬摂取1~6時間で発症します。
(e) 物理性蕁麻疹:機械性蕁麻疹、寒冷蕁麻疹、日光蕁麻疹、温熱蕁麻疹、遅延性圧蕁麻疹(圧迫部位に圧迫後3~8時間でみられる)、水蕁麻疹(水との接触)、振動蕁麻疹に分かれます。
(f) コリン性蕁麻疹:運動や緊張により体温が上昇すると点状に発症します。
(g) 接触蕁麻疹:原因物質に接触後数分ないし数十分以内で発症し、数時間以内に消退します。
(3)血管性浮腫:皮膚・粘膜の深部を中心とした限局性の浮腫です。通常の蕁麻疹に合併して、あるいは単独で発症します。
(4)蕁麻疹関連疾患:蕁麻疹様血管炎、色素性蕁麻疹、Schnitzler症候群、クリオピリン関連周期性症候群
- <検査>
- アレルギー性蕁麻疹が疑われる場合、血清中の抗原特異的IgE測定を行い、各抗原に対する過敏性を調べます(当院ではRAST法で判定)。
- 当院では、アナフィラキシーショックを引き起こす可能性のあるプリックテスト、スクラッチテストは行っていません。
- <治療>
- 特発性蕁麻疹は薬物療法で症状の鎮静化を図ります。刺激誘発型蕁麻疹は原因・悪化因子を除去・回避し、薬物療法を併用します。
- 薬物療法は、中枢組織移行性が少ない第二世代抗ヒスタミン薬が中心です。効果が得られなければ薬剤の増量、変更、補助薬の追加により効果をみていきます。
- 急性蕁麻疹の方は、抗ヒスタミン薬により症状が完全に抑制した後中止して下さい。症状消失後の予防内服期間は1週間程度です。
- 慢性蕁麻疹の方は、一つの抗ヒスタミン薬の効果は1〜2週間継続して判断して下さい。症状の改善に伴い抗ヒスタミン薬を徐々に減量し、3日に1回程度内服し症状が抑制されていましたら内服を中止し頓服にしてみて下さい。 症状消失後の予防内服期間は1〜2ヶ月が目安です。
- 抗ヒスタミン薬の副作用は、眠気、鎮静作用など。
- 血管性浮腫を伴う蕁麻疹にトラネキサム酸が有効です。
- 抗ヒスタミン薬で効果が得られない時には、H2拮抗薬、グリチルリチン製剤(注射)、抗不安薬、トラネキサム酸、漢方薬など補助療法を併用します。
-
<オマリズマブ(遺伝子組換え)>
- 製剤名:オマリズマブ(遺伝子組換え)注射用凍結乾燥製剤
- 薬効分類名:慢性蕁麻疹治療剤(ヒト化抗ヒトIgEモノクローナル抗体製剤)
- 商品名:ゾレア皮下注用75・150mg
- 2017年3月 気管支喘息治療剤であるオマリズマブ(遺伝子組換え)は、特発性(原因不明)慢性蕁麻疹に対する効能追加が承認されました。
<オマリズマブの適応条件>
(1)既存治療で効果不十分な患者さんに限ります。具体的には食物・物理的刺激等の蕁麻疹の症状を誘発する原因が特定されず、ヒスタミンH1受容体拮抗薬の増量等の適切な治療を行っても、日常生活に支障をきたすほどの痒みを伴う膨疹が繰り返して継続的に認められる場合です。
(2)12歳以上、妊婦・授乳婦には投与出来ません。
(3)血液検査でIgE抗体が高値の方。この薬剤はIgEに結合する抗体製剤でマスト細胞に結合するIgEを減らすことでじんま疹を抑えます。
(4)何らかの理由で、ステロイドやシクロスポリンの投与が出来ない方。当院ではこの薬剤を試す前にプレドニゾロン換算量15mg/日までのステロイドの短期投与を検討します。
(5)効いた人は5割、中止後3ヵ月でその効果は消失します。これを十分理解しそれでも試したいと思う方。
(6)3割負担で1回27,347円、通常12週まで3回投与しますが、増える場合もあります。
- 用法及び用量:通常、成人及び12歳以上の小児にはオマリズマブ(遺伝子組換え)として 1 回300mgを 4 週間毎に皮下に注射します。
- 患者さんは、ゾレア皮下注用150mg くすりのしおりをご覧下さい。
- 詳細は、日本皮膚科学会の蕁麻疹診療ガイドライン2018をご参照下さい。
- 薬疹とは、経口投与・非経口投与(注射など)を問わず、体内に摂取された薬剤自体ないしその代謝産物の直接的または間接的な作用によって誘導される皮膚粘膜病変を指します。その機序は、即時型及び遅延型のアレルギー作用(アレルギー性薬疹)と薬理作用(中毒性や不耐症)によるものです。発症までの期間は、多くは2週間以内ですが、発疹型により特徴があります。なお頻度は日本皮膚科学会誌文献より引用しております。
(1)播種状紅斑丘疹型(MP型):下記原因薬剤の全てに発症の可能性があります。
(2)多型紅斑型(EM型):下記原因薬剤の全てに発症の可能性があります。
(3)湿疹型:下記原因薬剤の全てに発症の可能性があります。
(4)Stevens-Johnson症候群型(SJS):高熱と共に皮膚粘膜の壊死性障害を来します。びらんもしくは水疱は、体表面積の10%未満であること。半数が1週間以内で発症。
(5)蕁麻疹型:約半数が投与同日に発症。
(6)ざ瘡型:ほとんど抗腫瘍薬。ゲフィチニブやエルロチニブという上皮成長因子受容体阻害薬(EGFRIs)を投与された45〜100%に見られます。
(7)固定疹
(8)紅皮症型
(9)紫斑型
(10)手足症候群:ほとんど抗腫瘍薬。分子標的薬のソラフェニブ、スニチニブで発症します。
(11)薬剤性過敏症症候群(DIHS):38℃以上の発熱、原因薬剤中止後も2週間以上遷延する多型紅斑型・紅皮症型薬疹、顔面の特徴的皮膚症状(顔全体に紅斑・浮腫、口囲の紅色丘疹・膿疱・小水疱・鱗屑)、肝機能障害、リンパ節腫脹、血液異常、発症後2〜3週間後にヘルペス科のウイルス(HHV-6・7、EBウイルス、サイトメガロウイルス)の再活性化が見られます。原因薬剤は限られ、抗けいれん薬(ラモトリギンに注目)75%、ジアフェニルスルホン、サラゾスルファピリジン、アロプリノール、ミノサイクリン、メキシレチンで発症します。半数以上が1ヶ月以上で発症。
(12)中毒性表皮壊死症(TEN):SJSの表皮剥離が進行したものと、突然全身性のびまん性紅斑が生じ急激に広範な表皮剥離を来すびまん性紅斑型があります。体表面積の10%を越える水疱、表皮剥離、びらんなどの表皮の壊死性障害が見られます。半数が投与3日以内に発症。
(13)乾癬型:循環器官用薬が多い。投与1ヶ月以上、最長5年1ヶ月で発症。
(14)苔癬型:半数は循環器官用薬。投与1ヶ月以内と1年以上に二分。
(15)その他:光線過敏型の代表的な原因薬剤は、サイアザイド系利尿剤ヒドロクロロチアジド(ARBとの合剤あり)、ニューキノロン系抗菌剤、ピロキシカム・アンピロキシカム、テトラサイクリン(ドキシサイクリンの頻度が多い)、前立腺がん治療薬フルタミド・ビカルタミドです。
- 最も頻度の高いMP型は、ウイルス性発疹症(伝染性単核球症など)と臨床的に鑑別することが難しく、麻疹・中毒疹型とも呼ばれています。
- EM型は、重症薬疹(SJS、TEN)へ移行する可能性があるため、注意深く経過観察していく必要があります。
- MP型、EM型、湿疹型の3型で全体の60%位を占め、重症薬疹はSJS、TEN、DIHS合わせて10%未満です。
<薬疹の原因薬剤別頻度:(1)〜(11)>
(1)抗菌薬:β-ラクタム系(セフェム系、ペニシリン系、カルバペネム系)が60%弱を占める。
(2)抗腫瘍薬:代謝拮抗薬、植物性アルカロイド、分子標的薬の順である。フルオロウラシル誘導体が最も多い。
(3)循環器官用薬:降圧剤が65%位占める。
(4)抗けいれん薬:カルバマゼピン(商品名テグレトール、レキシン)の頻度が高い。DIHS、紅皮症型が多い。
(5)消化器官用薬
(6)消炎鎮痛剤
(7)神経系用薬
(8)非イオン系造影剤
(9)総合感冒薬
(10)呼吸器用薬
(11)インターフェロン製剤:C型肝炎の治療に保険適応になってから増加しています。C型慢性肝炎に、ペグインターフェロンα-2b、リバビリン、テラプレビルの3剤併用療法を受けた患者の84.6%に薬疹を生じます。90%は湿疹型と軽症だが、一部に重症薬疹へ進展する可能性があるとの報告があります。
<小児の薬疹>
・1歳以下の乳児は極めて稀です。15歳以下の薬疹は、全体の1.8%と少数です。
・15歳未満の原因薬剤は、中枢神経系用薬42%、次いで抗菌薬、消炎鎮痛剤でした。発疹型は、固定疹30%、蕁麻疹型16%、播種状紅斑丘疹型12%、重症薬疹の報告もあります。特に抗けいれん薬による重症薬疹は、小児においても注意が必要です。
・小児に生じる急性発疹症は、まずウイルス感染症と非典型的な発疹で感染症に対し抗菌薬や消炎鎮痛剤が投与されている場合は薬疹(主に播種状紅斑丘疹型薬疹)を念頭に置く必要があります。例えば、EBウイルスによる伝染性単核球症にアンピシリンを投与するとしばしば薬疹(アンピシリン疹)を発症するのが有名ですが、ウイルス感染症が先行し引き続き薬疹を生じるタイプがあります。
<分子標的薬による皮膚障害>
・非小細胞肺がん、大腸がん、膵臓がん、頭頸部がんに投与されている上皮成長因子受容体阻害薬(EGFRIs)は、投与時に以下の皮膚障害がほぼ必発します。
・ざ瘡様皮疹:投与1〜2週間後に発症します。
・皮膚乾燥:投与開始3〜5週間後に発症し、長期継続します。
・皮膚掻痒症:ざ瘡様皮疹、皮膚乾燥に伴って起きます。
・爪囲炎:投与開始6〜8週間後に手足の爪に多発します、治療抵抗性で重症化しやすいです。患者さんのQOLを低下させます。
・キナーゼ阻害薬のソラフェニブ(腎細胞がん)、スニチニブ(腎細胞がん、消化管間質腫瘍)に手足症候群が起きます。手足症候群とは、手掌・足底に限局性の斑状の発赤で始まり、荷重部や外的な刺激を反復して受ける部位に非常に強い角化を起こす特徴があります。これは水疱形成へ進展し疼痛を伴う。従来の抗がん剤で起きる手足症候群とは異なります。
- <検査>
- 原因薬剤を調べる検査として、遅延型アレルギー検査のパッチテスト(陽性率34%)、即時型アレルギー検査の皮内テスト(陽性率68%)、リンパ球刺激試験DLST(陽性率60%、遅延型アレルギーで陽性率が高い)があります。
- 最も確実なのは、もう一度原因薬を内服していただく誘発試験(内服試験)です。しかしこの場合には原因薬をそのまま内服するのではなく、1/10~1/100あたりから投与する方が安全と言えます。自己判断で行わず、病院皮膚科専門医の指導の元で行って下さい。
- <治療>
- 薬剤中止または継続し、ステロイド外用薬などの局所療法で軽快した症例は、80%です。
- 発熱・肝障害など全身症状、粘膜疹を伴った、SJS、TEN、DIHSなど重症薬疹は、入院の上ステロイドの全身療法やステロイドパルス療法が必要な場合があります。
- 抗腫瘍薬やインターフェロン製剤の薬疹は、薬剤を中止せず継続できる症例があります。
- 重症薬疹(SJS、TEN、DIHS)については、日本皮膚科学会ホームページの皮膚科Q&A薬疹(重症)及び厚生労働省重篤副作用疾患別対応マニュアルをご参照下さい。
- 掌蹠膿疱症(しょうせきのうほうしょう)は、手掌(手のひら)と足蹠(足の裏)に無菌性の小膿疱(黄色い膿)が多発し、長い経過で出没を繰り返します。以下 掌蹠膿疱症をPPPと略します。割合を示す数値は文献より引用しています。
<発症誘因:PPPの8割の症例で(1)〜(3)の誘因が複合して関わっています>
(1)喫煙:PPP患者の喫煙率は80〜90%でPPPの発症と症状悪化に関わっています。禁煙をお勧めします。
(2)病巣感染:PPPの47%に歯性病巣(膿瘍を形成する根尖病巣や歯槽骨の骨吸収が見られる歯周病)が関与しています。PPPの22〜27%に扁桃病巣が関与しています。 学童期に扁桃炎を繰り返した既往のある方が目安です。喉にある口蓋扁桃(以下扁桃)が病気の起源になり、離れた部位に病状を引き起こす扁桃病巣疾患という概念があります。PPPはその代表的な疾患です。扁桃病巣疾患の患者さんは、喉にいる常在細菌に対して扁桃が過剰に免疫反応を起こし、産生された抗体やリンパ球が血液に乗って皮膚に運ばれ集まり皮膚組織を傷害します。歯性病巣治療と扁桃摘出がPPPに有効です
(3)歯科金属アレルギー:PPPの3%に歯科金属アレルギーが関与しています。金属アレルゲンによるパッチテストで歯科金属に陽性の患者さんは、歯科金属を除去するとPPPに有効です。
- <臨床症状>
- 1〜5mmの膿疱の多発に伴って紅斑を生じ、やがて小膿疱は褐色痂皮となり、周囲の紅斑部の鱗屑とともに剥がれ落ちることを繰り返します。最後に角化(角質増殖)が著明に残ることがあります。
- 爪病変(爪床に膿疱、爪甲変形や剥離、爪囲の発赤・腫脹・疼痛など)
-

多発する小膿疱と著明な角化・鱗屑
<合併症>
・掌蹠膿疱症性骨関節炎:PPPの10〜30%に見られます。付着部炎から骨髄にも炎症を来します。主に胸肋鎖骨部を侵し胸骨周辺や肩甲骨の疼痛と運動制限を来します。
・末梢関節炎、関節外症状
・アナフィラクトイド紫斑病とIgA腎症
・甲状腺疾患
・関節リウマチ
- <外用療法>
- (1)尿素軟膏やサリチル酸ワセリンで保湿を徹底します。
- (2)ステロイド外用薬:掻痒や紅斑が強い炎症部位に塗ります。
- (3)活性型ビタミンD3外用薬:膿疱の消失や角化の軽減に有効です。外用部位を越えて落屑(皮がむけてはがれ落ちる)を来します。(2)と(3)を混合せずに、各々の効果をうまく使い分けることをお勧めします。落屑が著しければ保湿し、ステロイド外用薬を減弱、亜鉛華軟膏で保護しながら表皮を整え、(3)を再開します。サリチル酸ワセリンと 活性型ビタミンD3外用薬の併用は、効果が減弱するためお勧め致しません。
- <病巣感染に対する治療>
- 扁桃摘出の有効率は、60〜88%です。また扁桃摘出後1年で8割、3年で9割の方が完治しているとの報告があります。
- 歯性病巣治療の有効率は、65〜73%です。
- <紫外線療法>
- 病巣感染が見つからず、外用療法の効果が得られない、掻痒が強く掻破が止まらないなどの症例に試みます。 PPPに保険適応である紫外線療法は、ターゲット型エキシマライト照射療法(当院で第一選択)、ナローバンドUVB療法とlocal bath PUVA療法があります。
- <その他の治療法>
- ビオチン療法:PPPに対するビオチン(水溶性ビタミン、欠乏症は稀)の効果は、医学的根拠が乏しいため、当院では未実施です。
- マクロライド系抗菌薬:膿疱が減少し、骨関節炎の疼痛軽減に使用します。
- 抗リウマチ薬・抗炎症剤: 抗炎症剤は骨関節炎の疼痛軽減に使用します。
- エトレチナート(商品名チガソン): PPPに保険適応です。催奇形性あり、使用中及び中止後女性は2年、男性は半年避妊が必要です。副作用として、肝障害と高率に皮膚粘膜症状があります。高齢者もしくは妊娠を希望されない難治例の方に使用します。
- 乾癬は厚い鱗屑と境界明瞭な紅斑を特徴とし、しばしば痒みを伴います。好発部位は被髪頭部・四肢伸側・腰臀部ですが、爪や外陰部を含めて全身の皮膚に生じます。発症年齢は20歳代から50歳代が多く、男女比は2:1と男性に多い傾向です。発症には人種差があり、日本人の0.1%に発症するとされ、欧米の2~3%に比較すると少ない。
<病因>
(1)多因子遺伝
(2)薬剤による誘発:β遮断薬・リチウム製剤・非ステロイド性抗炎症薬・クロロキン・インターフェロン製剤・乾癬の治療薬であるTNF-α阻害薬などで乾癬の発症、乾癬症状の悪化や乾癬様薬疹を誘発するとの報告があります
(3)細菌感染との関連性
(4)免疫学的異常:IL-23/Th17が持続的に活性化されています
(5)ケラチノサイトの分化・増殖の異常
<病型分類>
(1)尋常性乾癬:典型例は境界明瞭で扁平隆起した、銀白色の鱗屑を伴う紅色局面状皮疹を主体とします。丘疹や膿疱を呈することもあります。鱗屑を除去すると容易に点状出血が見られるアウスピッツ現象や外傷や物理的刺激により皮疹が誘発されるケブネル現象があります。爪母・爪床に生じたものを爪乾癬と呼びます(点状陥凹・混濁・肥厚)。なお頭皮症状、爪症状及び殿裂部と肛門周囲の症状は、将来的に関節症性乾癬を発症するリスクが上昇する症状とされています。
(2)関節症性乾癬:乾癬性関節炎とも呼ばれ、炎症性関節炎を伴う乾癬のことです。日本では乾癬患者の14.3%に発症することが報告されており、近年増加傾向にあります。関節症状の前に乾癬の皮膚症状が見られる症例が全体の約7割と多く、関節症状が先行する症例や同時に発症する症例もあります。診断には、CASPAR基準があります。鑑別診断として、関節リウマチ・変形性関節炎・強直性関節炎が挙げられます。関節症状として
・指趾炎:手足の指全体が腫れます
・付着部炎:骨に付着している靱帯や腱に痛みを感じます
・末梢関節炎:手足の指先の関節に腫れや痛みが出現します
・体軸関節炎:脊椎、頚椎や仙腸関節の関節が障害されます
(3)乾癬性紅皮症:全身の9割以上が乾癬の皮疹(膜様から粉状の鱗屑)で覆われた状態です。全身症状を呈し入院治療が必要な場合があります。
(4)滴状乾癬:上気道感染(原因菌はA群β溶連菌が多い)に引き続いて生じる雨滴状の小さな皮疹が主体の乾癬です。半年以内に消退することが多いが、再発を繰り返したり、尋常性乾癬に移行する例もあります。
(5)膿疱性乾癬:特に汎発性膿疱性乾癬は、急激な発熱とともに潮紅を伴う局面状に無菌性膿疱が多発する疾患です。乾癬全体の1%程度を占める稀な病型で、稀少難治性皮膚疾患として特定疾患に属します。汎発性膿疱性乾癬は、入院治療を行うのが原則です。詳細は日本皮膚科学会の膿疱性乾癬(汎発型)診療ガイドライン2010年をご参照下さい。
<乾癬の合併症:福岡大学医学部皮膚科学教授 今福 信一先生より引用>
(1)メタボリックシンドロームとして、肥満・高血圧・糖尿病・脂質異常症・高尿酸血症がみられます。40~50歳代で乾癬の症状がひどい方では、動脈硬化や心筋梗塞などの血管の病気を発症しやすいといわれています。
(2)ブドウ膜炎:乾癬患者さんの0.4~0.5%ほどがかかるといわれ、また関節症状のある方では、7~18%にみられます。
(3)うつ:25%の患者さんがうつ状態といわれます。うつはさらに心血管系疾患発症の危険性を増加させます。
- <重症度の評価>
- 乾癬の重症度を評価する方法として、PASIスコア、PGAスコアなどがあります。さらに患者のQOLを加えた、DLQIやPDIという評価法もあります。
- <治療>
- (1)環境因子に対する生活指導と悪化因子の除去
- 悪化因子である精神的ストレスや乾癬を誘発する薬剤の除去、アルコールを控える。禁煙、感染症の予防指導、肥満・メタボリック症候群の合併が多く食事指導を含め生活環境の整備も重要である。また適度な日光浴を勧めます。
- (2)外用療法:(a)〜(c)
- (a)ステロイド外用薬:炎症(紅斑)を速やかに抑えますが、長期連用すると皮膚萎縮、毛細血管拡張や副腎皮質機能抑制などを引き起こします。使用中止後の急性憎悪も報告され、症状の改善にしたがって使用量、使用回数、強さを徐々に下げてく必要があります。
- (b)活性型ビタミンD3外用薬:表皮の過剰な増殖や異常な分化を正常化し、鱗屑や浸潤(皮膚の盛り上がり)を抑えます。症状の寛解導入前はステロイド外用薬と活性型ビタミンD3外用薬を併用、症状の改善にしたがってステロイド外用薬を徐々に漸減し、寛解導入したら活性型ビタミンD3外用薬のみで維持していきます。
- (c)活性型ビタミンD3とステロイドの配合外用薬:当院ではステロイド外用薬や活性型ビタミンD3外用薬に代わり乾癬の外用療法の主役となっています。
- 平成26年9月カルシポトリール水和物とベタメタゾンジプロピオン酸エステル配合剤(商品名ドボベット軟膏)発売。1日1回塗布、1週間の使用量は90gまで。米国で4週間の研究において、乾癬の消失あるいは軽快の達成率は、配合剤治療群は活性型ビタミンD3外用薬治療群やステロイド外用薬治療群より良い結果でした。さらに52週間の臨床試験では患者の70〜80%が寛解あるいはほぼ寛解状態を達成しました。
- 平成28年6月マキサカルシトールとベタメタゾン酪酸エステルプロピオン酸エステル配合製剤(商品名マーデュオックス軟膏)発売。1日1回塗布、1日使用量は10gまで。
- 平成30年6月4日ドボベットゲルが発売、頭髪部へ塗布しやすい剤形です。
- 令和3年6月18日ドボベットフォームが発売、軟膏より皮疹の軽快達成率は高いようです。
- (3)紫外線療法:乾癬に保険適応である紫外線療法は、ナローバンドUVB療法とターゲット型エキシマライト照射療法があります。原則として、乾癬にはナローバンドUVBで皮疹がない部位を含めた全身照射が望ましいと思われます。全身照射あるいは内服・外用治療で治りにくい病巣(特に厚い鱗屑や頭髪で覆われた部位)に、ターゲット型エキシマライトで追加照射するのも効果的です。勿論難治性・抵抗性部位及び厚い鱗屑や頭髪で覆われた部位のみに、ターゲット型エキシマライト照射療法を行うことも出来ます。ナローバンドUVB療法とターゲット型エキシマライト照射療法は、組み合わせ治療が可能です。爪周囲の皮疹を伴う爪乾癬に、ターゲット型エキシマライト照射療法が有効です。
- (4)内服療法:当院では抗ヒスタミン薬とオテズラ錠
- 抗ヒスタミン薬:痒みを抑えるため、保険適応の塩酸エピナスチン(商品名アレジオン)、オロパタジン(商品名アレロック)を処方します。
-
<オテズラ錠>
- 薬効分類名:PDE4阻害剤、一般名:アプレミラスト。
- 2017年3月 乾癬の新しい治療薬 経口PDE4(ホスホジエステラーゼ4)阻害剤 オテズラ錠が発売されました。
- 適応と投与上の注意:小児、妊婦、授乳婦には投与出来ません。高齢者へは慎重に投与します。
- 効能・効果:局所療法で効果不十分な尋常性乾癬、関節症性乾癬。
- 効能・効果に関連する使用上の注意
- (a)ステロイド外用剤等で十分な効果が得られず皮疹が体表面積の10%以上に及ぶ患者。
- (b)難治性の皮疹又は関節症状を有する患者。
- (a)か(b) いずれかを満たす尋常性乾癬又は関節症性乾癬患者に投与することとなっています。
・乾癬患者の免疫細胞や表皮細胞ではPDE4が過剰に発現しており、細胞内cAMP濃度の低下により各種サイトカイン(TNF-α、IL-23、IL-17、 INF-γなど)の炎症性メディエーターの産生が亢進しています。なおPDE4は、cAMPを不活型のAMPに分解する酵素で免疫細胞内のシグナル伝達を調整しています。オテズラは、PDE4を阻害し細胞内cAMP濃度を上昇させ、その結果各種サイトカインやケモカインなどの炎症性メディエーターの産生を調整し、過剰な炎症反応が抑制されることにより、乾癬の症状が改善すると考えられています。
- 用法・用量:成人にはアプレミラストとして1日目朝10mg、2日目朝10mg夕10mg、3日目朝10mg夕20mg、4日目朝20mg夕20mg、5日目朝20mg夕30mg、6日目以降は朝30mg夕30mg経口投与、食前又は食後のいずれのタイミングでも服用できます。スターターパックには飲み始めから2週間分の薬剤が入っており、初回治療の漸増投与を簡便に行うことができます。
- 用法・用量に関連する使用上の注意:重度の腎機能障害患者では、本剤の血中濃度が上昇する可能性があることから、本剤を30mg 1日朝1回投与する等、減量も考慮し、慎重に投与すること。本剤による治療反応は、通常投与開始から24週以内に得られます。24週以内に治療反応が得られない場合は、本剤の治療計画の継続を慎重に再考すること。
- 代謝・排泄:CYP3A4 、CYP1A2及びCYP2A6で代謝、尿及び便に排泄されます。
- 併用注意:CYP3A4酵素誘導作用を有する薬剤(リファンピシン、フェノバルビタールカルバマゼピン、フェニトイン等)。本剤はCYP3A4で代謝されるため、CYP3A4酵素誘導剤を併用した場合に、本剤の血漿中濃度が減少する。
- 臨床効果(国内):効果がでるまでには時間がかかりますが、アプレミラスト30mgを1日2回 4か月服用すると皮疹がほぼ消失した(sPGA)割合が29%、皮疹がかなり改善した(PASI-75、PASIスコアが75%改善)割合が28%でした。
- 国内臨床試験では29.5%に副作用。重大な副作用は、ウイルス・細菌・真菌等による重篤な感染症とアナフィラキシー等の重篤な過敏症でした。
<オテズラ錠の特徴>
・内服薬です
・頭部、手足、爪などの難治部位の乾癬に有効と言われています。生物学的製剤と同等の効果が得られた症例もあります
・関節症性乾癬の指趾炎や末梢性関節炎に有効と言われています
・本剤とナローバンドUVB療法は同時併用が可能であり、本剤単独の症例より有効例が報告されています
・本剤の治療効果の判定は、投与開始から24週以内とされています。効果がなく中止の際は、漸減は必要ありません。本剤が有効であった患者さんも、中止後平均5週で皮疹が再燃すると報告されています
・処方前・処方中の血液検査などは、必要ないと言われています。しかし重度の腎機能障害患者に投与する場合は、腎機能を評価する検査が必要です
・発売開始より半年間の市販直後調査で発現した副作用のうち、約5%が重篤なものでした。なお 乾癬に併発した心筋梗塞で死亡した1例も含まれています
・クリニック(診療所)で処方を開始出来る薬剤となっております
- 薬剤費用:スターターパック(14日分)3割負担の患者さん 約6,700円。15日目以降の維持期 1日60mg14日分 3割負担の患者さん 約8,200円。なお 3割負担の患者さん、最初の4週間は約15,000円、以降4週間毎に約16,400円かかります。
- オテズラ錠による治療を現在受けている、または医師との相談によりオテズラ錠による治療を受けることを予定している患者さんは、バイオ医薬品企業 セルジーン社のHPをご覧下さい。
- (5)生物学的製剤:当院では未実施
雀卵斑(そばかす)
- 雀卵斑(そばかす)は、小児期〜思春期より顔面正中部・手背・腕など露出部に点状に多発する小色素斑で、夏季紫外線照射により悪化します。
- 鑑別診断として、遺伝性疾患の一表現として雀卵斑様皮疹があります。
- 自由・自費診療として光治療、ハイドロキノン外用で治療しています。
後天性真皮メラノサイトーシス
- 思春期から青年期に生じる顔面の両側性色素斑は、後天性真皮メラノサイトーシスと肝斑があります。
- 後天性真皮メラノサイトーシスは、思春期から30歳頃までの女性に好発する両側頬部の点状から小斑状に多発する青褐色斑~灰褐色斑です。個疹は点状から小斑状で局面ではなく、色むらあり、しばしば鼻翼部にも見られます。
- 病理組織学的には真皮内にメラノサイトが増強しています。(深いしみ)
- 自由・自費診療として光治療(Max Gを使用し有効例あり)、ハイドロキノン外用で治療しています。難治例があります。
肝斑(かんぱん)
- 肝斑は30歳代の女性の顔面に好発、女性ホルモンが発症に関与し妊娠を契機に発症します。最近、慢性の過刺激による炎症性色素沈着であるとの説があります。
- 症状は両頬骨部に左右対称境界明瞭な褐色斑で、前額部・人中(鼻と口の間)にも見られ、眼窩部には見られません。
- 病理組織学的には、表皮基底層のメラニン増加が見られ、メラノサイトが活性化し継続的にメラニン産生が過剰であることが病態です。
- トラネキサム酸とビタミンCの内服(保険適応)、自由・自費診療として光治療、ハイドロキノン外用で治療しています。治療開始時に、どちらかを選択して頂きます。
- レーザー治療は、照射後色調が増強するため適応外です。
老人性色素斑
- 老人性色素斑は、中年期以降顔面・手背・前腕伸側・体幹などに発する大小の褐色色素斑です。
- 顔面に多発する小斑型、こめかみなど顔面に少数個発し時に一部が隆起し老人性疣贅(いぼ)へ移行する大斑型などがあります。
- 老人性疣贅(いぼ)へ移行したものは、液体窒素療法とスピール膏貼付で治療致します。
- 症例により、光治療で自由・自費治療しています。
- 尋常性白斑は、表皮の色素脱失による白斑を特徴とする後天性進行性の難治性疾患です。白斑は次第に拡大・増加・融合し、やがて完全脱色素斑を呈します。人種差はありますが、全人口の約0.5~1%が罹患し、明らかな遺伝形式はないが尋常性白斑の20~30%に家系内発症が見られます。
<分類>
(1)非分節型:神経支配領域と関係なく生じます。粘膜型、四肢顔面型、汎発型、全身型が含まれます。
(2)分節型(5〜28%):皮膚の分節に一致する片側性の白班が生じ、顔面に好発します。分節が複数になることもあります。限局型、一部の粘膜型が含まれます。
(3)混合型
<原因>
(1)自己免疫説:汎発型尋常性白斑は自己免疫性甲状腺機能異常、悪性貧血、1型糖尿病、抗核抗体陽性例などと合併が多く見られ、自己免疫疾患である根拠となっています。
(2)色素細胞自己破壊説
(3)神経説
(4)生化学説
<鑑別診断>
(1)Vogtー小柳ー原田氏病:汎発性脱色素斑にブドウ膜炎・髄膜炎・難聴を合併します。
(2)サットン現象・サットン母斑:悪性黒色腫や色素性母斑に随伴して脱色素斑が生じることがあります。メラニン関連蛋白に対する自己免疫反応と言われています。
(3)感染症に伴う白斑:細菌(梅毒、ハンセン病)、ウイルス(HIV感染)、真菌(癜風)それぞれに白斑を伴うことがあります。
(4)白色粃糠疹(単純性粃糠疹):アトピー性皮膚炎の患児に多く見られ、俗に言うはたけです。
(5)老人性白斑:老化によるメラノサイトの減少と考えられます。
- <治療>
- (1)ステロイド外用薬:体表面積が10〜20%以下の白斑において、第一選択となります。
- (2)ナローバンドUVB療法:成人の尋常性白斑の方にはナローバンドUVB療法の治療効果が優れており、紫外線療法の中でも第一選択となります。標準的照射方法は、脱色素部(1〜2㎠)でMEDを測定します。70%MEDから照射開始、以後10%ずつ増量し臨床的に色素再生が確認出来るまで照射します。週に1〜3回で、6ヶ月間あるいは60回まで照射します。なお3日連続照射は避けること。
- (3)ターゲット型エキシマライト照射療法:海外ではナローバンドUVB療法より有効例が報告されていますが、日本では尋常性白斑に対する効果・副作用が未確定なので、ナローバンドUVB療法に反応しない顔面・頚部の白斑に試してもよいとされています。(2012年尋常性白斑診療ガイドラインより)当院では、顔面・頚部の小型で数が少ない白斑に、ターゲット型エキシマライト照射療法を第一選択にしてもいいと考えます。
- 詳細は、日本皮膚科学会尋常性白斑診療ガイドライン2025をご参照下さい。
- 多汗症とは、体温調節に必要な発汗の範囲を超えて過剰に発汗が認められ、日常生活に支障を来す場合に診断します。多汗症が問題となるのは、原因不明の局所的な発汗が半年以上続いている場合です。
- 局所性多汗症の一つである掌蹠多汗症は、情緒不安定、精神的緊張状態を基盤にして発症することが多いようです。
<局所多汗症の診断基準:局所的に過剰な発汗が明らかな原因がないまま半年以上認められ、以下の6項目のうち2項目以上あてはまる場合を多汗症と診断しています>
(1)最初に症状がでるのが25歳以下であること
(2)対称性に発汗がみられること
(3)睡眠中は発汗が止まっていること
(4)1週間に1回以上多汗のエピソードがあること
(5)家族歴がみられること
(6)それらによって日常生活に支障をきたすこと
- なお当院では、発汗検査(定性的測定法、定量的測定法)は行っていません。
<局所多汗症の重症度判定;自覚症状により>
(1)発汗は全く気にならず、日常生活に全く支障がない
(2)発汗は我慢できるが、日常生活に時々支障がある
(3)発汗はほとんど我慢できず、日常生活に頻繁に支障がある
(4)発汗は我慢できず、日常生活に常に支障がある
(3)と(4)を重症の指標にしています
- <治療法>
- 原発性手掌多汗症に2023年6月より、アポハイドローション20%が処方出来ます。
- 内服療法:原発性局所多汗症診療ガイドライン2015年改訂版では、頭部・顔面の多汗症に試してもいいとされています。
- (1)精神的緊張により発汗が強くなる方に、グランダキシン錠。
- (2)頭部顔面多汗症を含めた全身性多汗症の患者さんに、プロ・バンサイン錠15mg内服という選択肢もあります。
-
<プロ・バンサイン錠15mg>
- 一般名:プロパンテリン臭化物。日本で唯一、多汗症に対する保険適用を有する抗コリン薬です。
- 効能・効果:頭部顔面多汗症を含めた全身性多汗症。掌蹠多汗症に対しガイドラインの推奨度は、行うことを考慮してもよいが、十分な根拠がないとしています。
- 用法・用量:成人には1回1錠を1日3〜4回経口投与する。下記疾患がない若い方は、発汗を止めたい外出時に、1〜2錠/回服用することも可能です。食後より空腹時に服用するほうが有効な場合が多いです。
禁忌
(1)緑内障の患者(眼圧の上昇を起こし症状を悪化させるおそれがあるため)
(2)前立腺肥大による排尿障害のある患者(症状を悪化させるおそれがあるため)
(3)重篤な心疾患のある患者(心悸亢進を起こすおそれがあるため)
(4)麻痺性イレウスのある患者(閉塞状態を悪化させるおそれがあるため)
使用上の注意
(1)甲状腺機能亢進症、うっ血性心不全、不整脈のある患者(心悸亢進を起こすおそれがあるため)
(2)潰瘍性大腸炎のある患者(中毒性巨大結腸を起こすおそれがあるため)
(3)高温環境にある患者(発汗抑制が起こり、体温上昇のおそれがあるため)
(4)高齢者(抗コリン作用による眼の調節障害、口渇、便秘、排尿障害等があらわれやすいので、慎重に投与すること)
(5)妊婦・産婦・授乳婦・小児への投与は、安全性は確立していません
(6)自動車の運転等危険を伴う機械の操作に従事させないよう注意すること
併用注意
(1)三環系抗うつ剤(イミプラミン、アミトリプチリン)
(2)フェノチアジン系薬剤(プロクロルペラジン、クロルプロマジン、ジエチルペラジン等)
(3)モノアミン酸化酵素阻害剤
(4)ジゴキシン、メチルジゴキシン
- 副作用:眼の調節障害、口渇、便秘、排尿障害が、5%以上の頻度でみられます。
- 薬効薬理:抗コリン作用(アセチルコリンが受容体に結合するのを阻害する作用)、自律神経節遮断作用など。
- 詳細は日本皮膚科学会 原発性局所多汗症診療ガイドライン2023年改訂版をご参照下さい。
- ナローバンドUVB療法は、中波長紫外線(UVB)のうち治療に有効な波長(311±2nm)のみを選択的に発する蛍光ランプを用いて照射を行う最新の紫外線治療法です。PUVA療法のように前もって光感受性薬剤の塗布や内服は必要ありませんので簡便かつ安全です。
<UVBによる乾癬治療の作用機序>
(1)皮膚に浸潤した病因となるT細胞のアポトーシス誘導
(2)制御性T細胞(Tレグと称し、免疫細胞の攻撃を止める働きをします)の誘導
(3)サイトカイン産生抑制
(4)神経線維数の減少効果(掻痒感の改善効果)
- なお10歳未満の小児には、将来の副作用を鑑み照射出来ません。
- 当院で採用しております紫外線治療器は、(株)東芝医療用品 デルマレイ-200(タイプA・NB)です。
-

<保険適応疾患:赤字は当院で行っている疾患>
・尋常性乾癬(爪乾癬)
・類乾癬
・掌蹠膿疱症
・菌状息肉腫(症)
・悪性リンパ腫
・慢性苔癬状粃糠疹
・尋常性白斑
・アトピー性皮膚炎
・円形脱毛症
- <治療の実際>
- まず月曜・火曜・金曜日のいずれか午後に予約して頂き、背部にナローバンドUVBを5分照射します。24時間後に最少紅斑量MEDを測定し、最初の照射時間を決めます。
- 乾癬における標準的照射方法は、初回は50%又は70%MED照射で開始し、紅斑を生じない場合毎回20%ずつ照射量を増量、淡い紅斑がみられた場合前回と同じ照射量、境界明瞭な紅斑がみられた場合その際には照射せず次回は同量その後10%ずつ増量、痛みを伴う紅斑・浮腫性紅斑・水疱が生じた場合その症状が治るまで待ち照射量を半減その後10%ずつ増量します。
- 当院では、週に1・2回 診療時間内に照射します。
- ステロイド外用薬、活性型ビタミンD3外用薬又は活性型ビタミンD3とステロイドの配合外用剤を使用する外用療法とナローバンドUVB療法を併用する場合、最大照射量は2MEDでも効果が得られます。
- MEDが測定できない患者さんに、500mJ/㎠の照射量から開始、100mJ/㎠ずつ照射量を増量、週に2回照射、週に1回未満で維持するという照射方法があります。
- アトピー性皮膚炎では、50%MEDの照射量を継続するという照射方法があります。
- 寛解するまでには、約20回位要します。(個人差あり、疾患により異なります)
- 総照射回数を、400回以内とします。
- <当院の治療方針>
- 前記した伝統的な照射法もありますが、ターゲット型エキシマライトの照射法に習い、MEDを測定せずに、初回照射量(平均1MED 680mJ/㎠の50%又は70%に近い300〜400mJ/㎠から開始)及び至適照射量(照射後の紅斑をみながら、100mJ/㎠ずつ増量)を決めていく照射法を昨今実践しています。また寛解までの回数にこだわらずに、痒みや炎症を改善させるための治療として数回〜5回位照射を受けて頂いても結構です。
- <副作用>
- 急性:照射量の増量に伴い赤み、日焼け、水疱など
- 慢性:色素沈着、しわや乾燥など皮膚老化、色素斑など
- 発癌性:少ないが全くないとは言えない状態です。既往にPUVA療法をされた方は、皮膚癌(基底細胞癌)を発症する可能性がよりあると考えられます。(文献より)
- <ナローバンドUVB以外の紫外線療法>
- ナローバンドUVB療法で寛解しない掌蹠膿疱症、爪乾癬の患者様にはlocal bath PUVA療法という紫外線療法があります。local bath PUVA療法とは、0.0001%メトキサレン(光毒性物質)入り温水に手や足を15分間入浴し直後に長波長紫外線(UVA)を照射する方法です。
- ターゲット型エキシマライト照射療法(次参照)
- 2016年2月29日よりウシオ電機株式会社(純国産メーカー)のセラビーム®UV308 miniによるターゲット型エキシマライト照射療法を開始致しました。
- ターゲット型エキシマライト紫外線治療器の光源は、塩化キセノン(XeCl)エキシマランプで、波長は308nmです。(中波長紫外線UVBの波長は290~320nm、ナローバンドUVBは311±2nm)
- なお10歳未満の小児には、原則照射出来ません。
<UVBにおける乾癬治療の作用機序>
(1)皮膚に浸潤した病因となるT細胞のアポトーシス誘導
(2)制御性T細胞(Tレグと称し、免疫細胞の攻撃を止める働きをします)の誘導
(3)サイトカイン産生抑制
(4)神経線維数の減少効果(掻痒感の改善効果)
- <ターゲット型の必要性とエキシマライトの登場 >
- 全身照射するナローバンドUVB療法の普及に伴い(当院では2005年8月より開始)、健常部位への紫外線暴露を極力避け、病変部のみを局所照射できるターゲット型の紫外線治療器の必要性が高まってきました。またエキシマライトは、ナローバンドUVBに比べて輝度が高く、より高輝度の光を短時間で照射することで、同じ照射量でも高い深達度と光量の確保が期待できると考えられています。
- <治療器の特長>
- 健常部位の紫外線曝露を回避し、局所照射が出来ます。照射面積は約50mm x 50mmで、付属の照射アタッチメント6種を使い患部の大きさに合わせた効率的な照射が出来ます。また横窓(患部確認窓)から照射位置が見えるので患部に正確に照射することが出来ます。
- ナローバンドUVB療法後に残存する難治性・抵抗性部位や厚い鱗屑や頭髪で覆われた紫外線の届きにくい部位に照射出来ます。ナローバンドUVB療法との組み合わせ治療が可能です。
- ナローバンドUVBに比べ輝度(光強度)が高く、照射時間が非常に短いため(日本人の平均1MED 300mJ/㎠を約12秒 照射照度25mW/㎠とした場合、ナローバンドUVBでは1分43秒 照射照度2.9mW/㎠)、大きな病変(分割し早く照射)や点在する病変部にも照射出来ます。
- 本体が6kg、ハンドピースが1kgと軽量で省スペース、持ち運びも自由、移動が簡単です。
- エキシマフィルター搭載:人体に有害な短波長域をエキシマフィルターで制御することで、患部に対する効果的かつ安全性に配慮した照射を可能としました。照射後に見られる、紅斑や色素沈着の副作用はかなり軽減出来ます。
<保険適応疾患:赤字は当院で行っている疾患>
・尋常性乾癬(爪乾癬)
・類乾癬
・掌蹠膿疱症
・菌状息肉腫(症)
・悪性リンパ腫
・慢性苔癬状粃糠疹
・尋常性白斑
・アトピー性皮膚炎
・円形脱毛症
- 保険適応外ですが、結節性痒疹、難治性手湿疹(異汗性湿疹を含む)、扁平苔癬、強皮症、日光蕁麻疹、毛孔性紅色粃糠疹、皮膚リンパ球種などに有効例があります。
<ナローバンドUVB療法より優れた効果が期待できる疾患>
・頭皮部の尋常性乾癬
・爪乾癬
・掌蹠膿疱症
・尋常性白斑(顔面・頚部の小型で数が少ない白斑)
・円形脱毛症
・結節性痒疹
- <白斑治療におけるイスラエル Dr. David Friedmanのプロトコール>
- (1)初回照射量
- 眼窩周囲 100mJ/㎠
- 顔面・首、鼠径部・腋窩 150mJ/㎠
- その他の部位 200mJ/㎠〜
- (2)2回目以降の照射量
- 変化なし、24時間以内に紅斑が消退⇒照射量を50mJ/㎠増量。
- 紅斑が24~48時間持続⇒前回照射量維持。
- 紅斑が48~60時間持続⇒照射量を50mJ/㎠減量。
- 紅斑が60時間以上持続⇒治療延期し次回は照射量を100mJ/㎠減量。
- <照射方法について>
- 他疾患の患者さんは、上記プロトコールを参考に、初回照射量及び至適照射量を決めていきます。(他疾患の初回照射量例として、眼窩周囲 150mJ/㎠、顔面・首、鼠径部・腋窩 200mJ/㎠、その他の部位 300mJ/㎠〜)
- 紫外線により常に赤くなるスキンタイプⅠとⅡの患者さんは、初回照射量を減量することがあります。
- 当院では、週に1・2回 診療時間内に照射します。
- 照射回数の目安は、乾癬・アトピー・脱毛症・痒疹は寛解まで約20回位、白斑は約50〜60回(半年)。掌蹠膿疱症は、難治例あり。痒疹は、寛解後 漸減照射することがあります。
- <副作用>
- 紅斑、水疱形成、色素沈着
- 長期的な紫外線照射による発癌性のリスクは、累積照射量が増えるとあがると言われています。ナローバンドUVBでは、基底細胞癌の発症率がわずかに上昇すると報告されています。エキシマライトに関しては、症例の集積が待たれます。
尋常性ざ瘡(にきび)
- にきびの悪化要因となる生活習慣(寝不足、不規則な生活、過剰なストレスの蓄積、運動不足、過食、糖分と脂分の摂り過ぎ、過度の飲酒、誤ったスキンケア・メイクなど)を見直して頂きます。
- 難治性の大人のにきびは、ストレスやホルモンバランスの乱れが原因となり、自由・自費診療を含めて治療法を検討して頂きます。
- <美容形成目的の自由・自費診療>
- 光治療:皮脂・膿が出やすくなり、にきび菌を殺菌します。中等症以上の患者さんに。
- <重症度の基準>
- 軽症は、片顔に炎症性皮疹(赤いブツブツや黄色い膿を持つにきび)が5個以下。
- 中等症は、片顔に炎症性皮疹が6個以上20個以下。
- 重症は、片顔に炎症性皮疹が21個以上50個以下。
- 最重症は、片顔に炎症性皮疹が51個以上。
- にきびといえば尋常性ざ瘡をさしますが、新生児ざ瘡、男性ホルモン性ざ瘡、ステロイドホルモンなどによる薬剤性ざ瘡、毛包虫(ニキビダニ)性ざ瘡、集簇性ざ瘡、酒さ性ざ瘡、老人性面皰、日光暴露による夏期ざ瘡など多くの種類があり、病態を理解して適切な治療が必要です。
尋常性ざ瘡(にきび)の外用治療薬:(1)〜(5)
- (1)過酸化ベンゾイル(Benzoyl Peroxide:BPO)含有製剤:(a)〜(c)
- 過酸化ベンゾイルは、角質剥離作用と抗菌作用により、にきびの炎症性皮疹(紅色丘疹:赤いにきび、膿疱:膿がたまった黄にきび)及び非炎症性皮疹(面皰・コメド、白色面皰と黒色面皰あり)を減少・改善させます。また、日本皮膚科学会尋常性ざ瘡ガイドライン2016では、炎症性皮疹を有するにきびに使用することを強く推奨しています。
- 過酸化ベンゾイル含有製剤の副作用によるアレルギー性接触皮膚炎は、1ヶ月以内に、比較的高頻度の2.7%に発症することが、平成29年1月の学会誌で発表されました。アダパレン、次いで過酸化ベンゾイルとにきび治療薬が発売されてから、我々皮膚科医はにきびの始まりである面皰を予防するため、全顔塗布を勧めてきました。今回の発表は、使用1ヶ月以内は外用量を少なくし、炎症性皮疹と面皰に点々と塗布する外用指導が必要であるという、警鐘を鳴らしました。
- (a)デュアック配合ゲル
-

- 2015年7月販売。過酸化ベンゾイル3%とクリンダマイシン1%の合剤で、角質剥離作用、抗菌作用、抗炎症作用を有しています。本剤の基剤には添加物として保湿成分が含まれています。
- 1日1回洗顔後外用。使用開始年齢は、12歳以上が望ましい。
- 全顔に塗布する場合の目安は、このチューブでは2FTU 約0.6g(1FTUとは人差し指の先から第一関節までの長さ)です。
- 冷蔵庫(2〜8℃)に保管。毛髪や着色繊維などを退色させる可能性があります。
- にきびの炎症性皮疹は、塗布2週間で62.5%、12週間で88.6%減少しました。
- デュアック配合ゲル1日1回塗布群は、クリンダマイシン1%(ダラシンTゲル1%)1日2回塗布群に対し、2週後より有意に皮疹数が減少しました。
- デュアック配合ゲルを用いた12週間を越える長期臨床試験は行われておらず、炎症性皮疹の大部分が改善する12週間を目安に、面皰治療を主体としたアダパレン単独又は過酸化ベンゾイル単独の外用治療に移行すべきとの見識があります。
- 主な副作用は、乾燥、接触皮膚炎、紅斑、皮膚剥脱、掻痒症でした。重大な副作用として大腸炎の報告があります。なお副作用は、外用開始3週間以内に発現すると言われています。
- デュアック配合ゲルでは、クリンダマイシン耐性アクネ菌の検出株数は、ベースラインと比べ、12週時で減少していました。
- <デュアック配合ゲル外用に関する当院の方針>
- デュアック配合ゲルを外用する前に、皮膚の乾燥・荒れ・痒みは治してから外用を開始して下さい。特に20歳前後の若い女性にお勧めします
- 初めてデュアック配合ゲルを外用する患者さんには、最初の2週間、1/4 FTU(FTUは上記参照)の外用量をにきびのみに点で塗って頂きます。引っ掻いている傷は、避けて下さい。
- 副作用がない又は軽微な患者さんには、1ヶ月位かけて、1/2FTU・1FTUと外用量を徐々に増やして頂きます。
- 副作用がない場合、にきび予防として、2FTUまでの外用量を、全顔に面で塗ってもよいと指示することがあります。
- (b)ベピオゲル2.5%
-

- 2015年4月販売。過酸化ベンゾイル2.5%。抗菌薬が配合されていないため、にきびが寛解した後、継続使用に向いています。
- 1日1回洗顔後外用。使用開始年齢は、12歳以上が望ましい。
- 全顔に塗布する場合の目安は、このチューブでは1FTU 約0.5g(1FTUとは人差し指の先から第一関節までの長さ)です。
- にきびの炎症性皮疹は、塗布2週間で36.4%、12週間で73.3%減少しました。
- 主な副作用は、皮膚剥脱、刺激感、紅斑、乾燥でした。
- (c)エピデュオゲル
-

- 2016年11月販売。アダパレン0.1%と過酸化ベンゾイル2.5%の配合剤であり、各単剤よりも皮膚刺激が発現するおそれがあるため、本剤よりも先に各単剤による治療を考慮することとなっております。副作用より、治療効果を優先したい重症・最重症のにきび患者さんに、お勧め出来ると言われています。
- 1日1回洗顔後外用。使用開始年齢は、12歳以上が望ましい。
- にきびの総皮疹は、塗布12週間で77.3%減少しました。比較したディフェリンゲルとは統計的有意差(p<0.001)が認められました。
- 副作用の発現率は10.8%(女性は男性の倍近い)認められ、主な副作用は皮膚刺激、皮膚疼痛、アレルギー性皮膚炎でした。なお副作用により投与中断に至った症例は0.3%、投与中止に至った症例は2%ありました。
- (2)レチノイド外用薬
- ディフェリンゲル0.1%
-

2017年11月上旬出荷よりデザイン変更
- 2008年10月販売。日本皮膚科学会の2008年尋常性ざ瘡ガイドラインによると、軽症から重症のざ瘡に対し、アダパレン(ディフェリンゲル0.1%の一般名)単独外用及びアダパレン外用と抗菌薬外用の併用は、強く推奨されています。また、炎症性皮疹が軽快したざ瘡に対し、アダパレン外用の継続を強く推奨しています。さらに面皰を早く改善させたい場合は、過酸化ベンゾイル含有製剤より適しているとの報告があります。
- 1日1回就寝前洗顔後外用、外用前に保湿をして下さい。使用開始年齢は、12歳以上が望ましい。
- 全顔に塗布する場合の目安は、このチューブでは1FTU (1FTUとは人差し指の先から第一関節までの長さ)です。
- にきびの炎症性皮疹は、塗布12週間で63.2%減少しました。
- 主な副作用は、皮膚乾燥、皮膚不快感、皮膚剥脱、紅斑、掻痒でした。副作用は通常軽度で、ほとんど使いはじめらか2週間以内にあらわれ、その後やわらいできます。副作用が強い場合は、ご相談下さい。
- (3)抗菌外用薬:4週間で効果が認められない場合は使用を中止する。炎症性皮疹が消失した場合には継続使用しない。また、長期使用時の薬剤耐性菌出現が懸念されていますので、使用開始3ヶ月後に中止することが望ましいと言われています。
- アクアチムクリーム1%(一般名ナジフロキサシン):1993年9月販売。1日2回洗顔後塗布。4週間後の有効率は81.3%。
- アクアチムローション1%(一般名ナジフロキサシン):1999年6月販売。1日2回洗顔後塗布。4週間後の有効率は84.4%。
- ダラシンTゲル1%(一般名クリンダマイシンリン酸エステル製剤):2002年9月販売。1日2回洗顔後塗布。4週間後の有効率は72.5%。
- ダラシンTローション1%(一般名クリンダマイシンリン酸エステル製剤):2010年5月販売。1日2回洗顔後塗布。
- (4)非ステロイド系消炎外用剤:面皰・掻痒を伴うにきびに試す。
- (5)イオウ含有製剤(イオウカンフルローション):面皰 、ニキビダニに有効。
- 詳細は、日本皮膚科学会尋常性ざ瘡治療ガイドライン2023をご参照下さい。
にきび痕
- 赤みと色素沈着のにきび痕に、自由・自費診療として光治療が有効です。
- 円形脱毛症(以下AAと略します)は、後天性脱毛症の中でも最も頻度の多い疾患で、人口の0.1~0.2%の発症率と言われています。自覚症状や前駆症状などを欠き、円形から斑状の脱毛斑が頭部のみならず毛髪が存在するあらゆる部位に生じます。AAの方に爪変化があり、爪甲に小さな点状陥凹が多く見られます。
<臨床分類>
(1)通常型円形脱毛症:単発型(脱毛斑が単発のもの)多発型(複数の脱毛斑を認めるもの)
(2)全頭脱毛症:脱毛巣が全頭部に拡大したもの
(3)汎発型脱毛症:脱毛が全身に拡大したもの
(4)蛇行状脱毛症(ophiasisオフィアシス):頭髪の生え際(特に後頭部)が帯状に脱毛するもの
<重症度分類:アメリカのAA評価ガイドラインによる重症度分類を記します。S0〜5、B0〜2>
S0:脱毛がみられない
S1:脱毛巣が頭部全体の25%未満
S2:脱毛巣が頭部全体の25~49%
S3:脱毛巣が頭部全体の50~74%
S4:脱毛巣が頭部全体の75~99%
S5:100%(全頭)脱毛
B0:頭部以外の脱毛なし
B1:頭部以外に部分的に脱毛がみられる
B2:全身全ての脱毛
- AAは一般的に脱毛巣の範囲が広い程重症で難治です。Bに関係なくS2以上を重症例と考えます。
- S2以下の回復率は56%、S3以上の回復率は3.7%との報告があります。蛇行状脱毛症は、予後が悪いです。
<病因・病態>
・疲労や感染症などストレスを引き金に、毛包由来の自己抗原を標的にした自己免疫反応が誘発されると想定されています。明らかな誘因がないことも多くあります。甲状腺疾患、尋常性白斑、SLE、関節リウマチ、重症筋無力症などの自己免疫疾患と合併することがあります。
・家族内発症があります。
・アトピー性疾患(気管支喘息、アトピー性皮膚炎、軽度のアレルギー性鼻炎)と合併します。
・AAの発症に、精神的ストレスの関与が明らかでない場合もあります。
<トリコスコピー所見:トリコスコピーとは毛髪もしくは頭皮の疾患についてダーモスコピーを用いて観察する手段です>
(1)通常型円形脱毛症の所見
・回復中に短軟毛 :7割に見られる
・非常に多数の黄色点 (皮脂と不完全に形成された毛幹の混合物):6割に見られる
・切れ毛・折れ毛 (障害された毛幹):4割に見られる
・黒点(切れた毛髪の基部):4割に見られる
・漸減毛(感嘆符毛とも呼び、急速に退行期・休止期に移行したため毛直径が縮小した像。毛の基部で毛直径の縮小が見られる肘折れ毛は一種の漸減毛):3割に見られる
(2)蛇行状脱毛症(ophiasisオフィアシス)の所見
・帯状の脱毛内に瘢痕性脱毛症の所見(毛孔消失、毛孔周囲鱗屑、毛孔周囲紅斑)が見られます
- <治療>
- 15歳以下(回復率が低い)と16歳以上の成人では、治療方針が異なる場合があります。15歳以下には、ステロイド局所注射療法(痛い)ステロイド内服療法及び静注ステロイドパルス療法は、推奨されていません。
- 当院では、ステロイド外用薬と塩化カルプロニウムの外用療法、セファランチン内服、液体窒素のスプレー式冷却療法、前記治療に抵抗する方はグリチロンや漢方薬内服の試みを行っています。液体窒素のスプレー式冷却療法は、2017年発表された計353例の症例集積研究で、約6割の患者で効果が認められたと報告しています。
- 中波紫外線療法としてターゲット型エキシマライト照射療法とナローバンドUVB療法が2020年4月より保険適応になりました。
- 脱毛が急速に進行しているS2以上(重症例)の成人の患者さんに、ステロイドパルス療法(入院の上)ないしステロイド内服療法を行う場合があります。治療前に全身に至るスクリーニング検査が必要なため、病院皮膚科をご紹介致します。
- 当院では、年齢を問わず症状の固定したS2以上に行う、SADBEないしDPCPを使った局所免疫療法は行っていません。
- 詳細は、日本皮膚科学会円形脱毛症診療ガイドライン2024をご参照下さい。
<男性型脱毛症 Androgenetic Alopecia AGAの診断:下記条件を満たすものをAGAと診断>
(1)脱毛開始時期が思春期以降である
(2)特徴的な脱毛パターン:額の生え際の後退、前頭部と頭頂部の毛髪が薄くなる
(3)抜け毛が進行性である(徐々に進行)
(4)親、兄弟や祖父に脱毛症を認めることが多い(遺伝的素因を有する)
(5)毛髪の軟毛化:長径及び長さの減少
<AGAの鑑別診断>
(1)頭部全体が疎になる円形脱毛症の亜型
(2)慢性休止期脱毛
(3)膠原病や慢性甲状腺炎などの全身性疾患に伴う脱毛
(4)貧血、急激なダイエット、その他の消耗性疾患などに伴う脱毛
(5)治療としてのホルモン補充療法や薬剤による脱毛 など
- <AGAの分類>
- 日本では緒方の分類
- 欧米ではNorwood/Hamiltonの分類
- 現在日本では、Norwood/Hamiltonの分類に高島分類の頭頂部が薄くなる II vertex を加えた分類が広く使用されています。
- AGAの進行パターンは、額の生え際から後退していくパターン、頭頂部から薄くなるタイプ、これらの混合タイプなどさまざまな脱毛の進行パターンがあります。
<AGAのトリコスコピー所見>
・脱毛部位の2割以上が短軟毛化(毛直径の不均一性)
・毛孔周囲の色素沈着は、6〜7割に見られます
・黄色点(皮脂と不完全に形成された毛幹の混合物)は、2〜3割に見られます
・黒点(切れた毛髪の基部)と切れ毛(障害された毛幹)は、見られません
<AGAの薬物療法:20歳以上の男性が対象、自由・自費診療>
・フィナステリド錠「クラシエ」:プロペシアのジェネリック医薬品
・ザガーロ:発毛・育毛効果は、プロペシアと比べ、優っているとの報告があります
・デュタステリド「サワイ」:ザガーロのジェネリック医薬品
- 詳細は、男性型および女性型脱毛症診療ガイドライン2017年版をご覧下さい。
プロペシア
- 2005年12月男性型脱毛症用薬としてプロペシアが日本で承認されました。プロペシアは米国をはじめ世界60カ国以上で承認されており、安全性と効果も確立されています。プロペシアには精巣などから分泌される男性ホルモンの一種テストステロンから抜け毛の原因物質ジヒドロテストステロン(DHT)へ変換する酵素(5α-還元酵素)を阻害する働きがあります。
- 国内臨床成績(第Ⅱ/Ⅲ相二重盲検比較試験)の結果ですが、24歳から50歳の男性型脱毛症患者(Modified Norwood-Hamilton分類:Ⅱvertex、Ⅲvertex、Ⅳ及びⅤ)414例を対象とした48週間のプラセボ対照二重盲検比較試験において、頭頂部毛髪の変化を写真により7段階で評価した結果、投与前と比べ48週で改善と判定されたのは、1mg投与群で58.3%、プラセボ群(5.9%)と比較して統計的に有意な改善を示しました。また48週間の二重盲検比較試験終了後通算96週間に至る長期投与試験において有効性は維持することが示されました。
- 二重盲検比較試験とは、被験者、医師、関係者がどの治療群に割り振られたのか全く知らない状態で行われる試験です。
- より高い治療効果が期待できる方:治療開始時年齢が40歳未満、治療開始時に中程度(Norwood/Hamiltonの分類でⅣ以下)以下の進行の方
- <使用上の注意について>
- 臨床検査結果では血清前立腺特異抗原(PSA)濃度が約40%低下したため前立腺癌診断の目的でPSA濃度を測定する場合2倍した値を目安として評価して下さい。
- プロペシアの成分であるフィナステリドは、ドーピング検査『1.常に禁止される物質と方法』の『S5.利尿剤と隠蔽剤』のカテゴリーで、α-還元酵素阻害剤の例示物質に挙げられています。プロペシアの成分であるフィナステリドはドーピング禁止物質のため、ドーピング検査の対象となる可能性があるスポーツ選手には処方出来ません。
- プロペシアは長期投与になるため定期的な血液検査(肝機能検査を含む)をお勧めします。
- <プロペシアの副作用について>
- 主な副作用(発現率は0.7%)は、性欲減退、片側性乳房肥大でした。なお、投与中止後も持続した症例があります。重大な副作用として、肝機能障害があります。
- プロペシアの長期投与患者が発症するリスクのある前立腺癌を早期に発見するには、50歳を過ぎてプロペシアを服用されている方は、健康診断などでPSA検査を定期的に受けることをお勧めします。
フィナステリド錠1mg「クラシエ」(プロペシアのジェネリック医薬品)
- 2016年2月18日プロペシアのジェネリック医薬品であるフィナステリド錠0.2mg・1mg「クラシエ」が製造販売承認を取得し、4月21日(株)クラシエ薬品より発売されました。
- 当院では、フィナステリド錠1mg「クラシエ」のみ取り扱い、包装規格は28錠(PTPシート14錠X2)と140錠(PTPシート14錠X10)の2種類です。バラで90錠入り薬瓶の規格はありません。
- 服用における注意点は、プロペシアと全く同じです。
- 診察料(初診料4,000円、再診料1,000円)及び薬剤費(28日分5,900円、140日分29,000円 )は全額自己負担となります。なお不要な薬剤の返品や返金はお受けできませんので了承下さい。
ザガーロ
- AGA(男性型脱毛症)の治療薬ザガーロ(一般名デュタステリド)は、2016年6月13日より発売を開始致します。(韓国に次ぎ2番目の2015年9月28日承認)
- ザガーロの一般名デュタステリドは、2009年9月前立腺肥大症治療薬として承認を得ているアボルブカプセルと同一であり、アボルブカプセルの臨床実績と国際的な評価より、ザガーロの安全性に関しては問題ないと考えます。
- 効能・効果:ザガーロは、テストステロンをより活性の高いジヒドロテストステロン(DHT)に変換する1型及び2型の5α還元酵素を阻害し、DHT濃度を低下させることでヘアサイクルの正常化を促し、発毛及び育毛効果や脱毛の進行予防効果を示します。(正常時の毛髪成長期は2〜6年、AGAにおける毛髪成長期は数ヶ月〜1年と短い)
- ザガーロ0.5mgで投与24週時、血清中DHT濃度は90%減少、頭皮中DHT濃度は51%減少、毛髪数のベースラインからの変化量は94本増加しました。(頭頂部の直径1インチ2.54cm円内における直径30μm以上の非軟毛の数)
- 用法・用量ですが、20歳以上の男性に、デュタステリドとして0.1mgまたは0,5mg(推奨)を1日1回経口投与します。治療効果を評価するためには、通常6ヶ月間の治療が必要です。6ヶ月以上投与しても改善がみられない場合には投与を中止すること。
- 禁忌は、本剤の成分及び他の5α還元酵素阻害薬に対し過敏症の既往歴のある患者、女性(妊産婦、授乳婦等)、小児、重度の肝機能障害のある患者です。
- 併用注意として、本剤は、主としてCYP3A4で代謝されるため、CYP3A4阻害作用を有する薬剤(ケトコナゾール、HIV治療薬リトナビル等)との併用により本剤の血中濃度が上昇する可能性があります。
- 使用上の注意として、デュタステリドは、前立腺肥大症患者に0.5mg/日投与した場合、6ヶ月後にPSA(血清前立腺特異抗原)値は約50%減少させます。本剤を6ヶ月以上投与している患者のPSA値を評価する際には、測定値を2倍した値を目安として基準値と比較して下さい。
- ザガーロ服用中、及び最後にザガーロを服用した日から6ヶ月間は献血しないで下さい。
- 発毛及び育毛効果ですが、投与開始24週時における毛髪数のベースラインからの変化量は、プロペシア1mgに比べザガーロ0.5mgは1.58倍、毛髪の太さのベースラインからの変化量は、プロペシア1mgに比べザガーロ0.5mgは1.45倍、硬毛数のベースラインからの変化量は、プロペシア1mgに比べザガーロ0.5mgは1.26倍と報告されています。以上発毛及び育毛効果は、ザガーロ0.5mgがプロペシア1mgを上回った(優越性あり)結果です。
- 韓国での投与試験の結果ですが、プロペシア1mgを6ヶ月間投与されるも改善を示さなかった症例にザガーロ0.5mgを6ヶ月間投与したところ、77.4%に改善効果が見られました。
- <ザガーロの副作用について>
- 国内長期投与試験(52週間)における副作用の発現率は16.7%。主な副作用は、勃起不全、リピドー減退、射精障害でした。頻度不明ですが、精巣痛の報告もあります。これらの副作用はザガーロの服用中止後も持続する場合があります。なお国際共同試験では、プラセボ(偽薬、有効成分が含まれていない薬)でも同様の副作用報告がありました。
- 男性の生殖能力への影響は知られていませんが、精子の数や精液量を減らしたり、精子の運動を弱めてしまう可能性があります。(平均減少率は20%位)
- ザガーロの長期投与患者が発症するリスクのある前立腺癌を早期に発見するには、50歳を過ぎてザガーロを服用されている方は、健康診断などでPSA検査を定期的に受けることをお勧めします。
- <ザガーロの副作用について最近の知見>
- 有害事象についてはプロペシア(フィナステリド)との大きな差はなく、ザガーロ特有の重篤な性機能障害はないと考えられています。さらに、投与終了時まで持続した一部の有害事象も、投与終了後には回復しています。これらのことより、ザガーロはプロペシア(フィナステリド)と同様、忍容性は高いと考えられます。
- 投与開始初期に性機能障害の訴えが多く、投与中に消失すること、長期投与試験のほうが性機能障害の頻度が高いことから、ノセボ効果(反偽薬効果)があると指摘されています。ザガーロの場合のノセボ効果は、性機能障害が起こるかもしれないと事前にしっかり説明されるので、内服を開始すると心理的に障害があるように感じてしまう、投与開始後しばらく経つと大きな障害がないことに気付き、安心して訴えが少なくなる。また全員実薬を服用することが分かっている長期投与試験では、心理的に有害事象の訴えが多くなると推測されます。
- <規格、自費負担など>
- 1箱30錠包装の規格ですので、処方単位は30錠ずつとなります。プロペシアの様なバラの包装はありません。
- 保険適応ではありません、診察料(初診4,000円、再診1,000円)及び薬剤費(30日分9,800円 )は全額自己負担となります。なお不要な薬剤の返品や返金はお受けできませんので了承下さい。
- 原則90錠までの処方ですが、長期出張・海外赴任などの場合、処方日数はご相談に応じます。
- ザガーロ0.5mgの使用期限は製造から3年です。
デュタステリドカプセル0.5mg「サワイ」(ザガーロのジェネリック医薬品)
- 2020年10月5日ザガーロのジェネリック医薬品であるデュタステリド0.5mg「サワイ」が製造販売承認を取得し、同年11月(株)沢井製薬より発売されました。
- 1箱30錠包装の規格ですので、処方単位は30錠ずつとなります。
- 服用における注意点は、ザガーロと全く同じです。
- 診察料(初診料4,000円、再診料1,000円)及び薬剤費(30日分7,000円)は全額自己負担となります。なお不要な薬剤の返品や返金はお受けできませんので了承下さい。
- 陥入爪とは、爪甲が軟部組織である側爪郭を損傷し(爪の角が中の組織に刺さる)炎症を引き起こした状態です。深爪によって爪甲を短く切ると、爪甲の先端は側爪郭へ食い込み、その結果として陥入爪が発症します。
- <陥入爪になり易い方>
- (1)巻き爪の方。
- (2)爪甲の幅が広い方。
- (3)外反母趾の方。
- (4)足に大きな力がかかるスポーツを行っている方。
- (5)抗がん剤治療としてEGFR阻害薬を使用している方。
- <陥入爪、巻き爪の治療>
- 爪甲の先端を延長する、爪甲と爪郭の間に空間を作る、爪甲の幅を狭くするなどが挙げられます。具体的には、下記(1)(2)の方法があります。現在矯正は行っていません。
- (1)コットン綿を使った爪おこし:入れ忘れた古いコットン綿に注意して下さい
- (2)アンカーテーピング(テープ法): 陥入が軽度な症例に
- 炎症や感染症を伴った症例はそれを治す事を優先し、肉芽形成した症例は肉芽組織を液体窒素による冷凍療法と硝酸銀で腐食させて治療致します。
- 皮膚細菌感染症と診断する場合、細菌培養で細菌が分離された病変部に感染症状、つまり発赤、腫脹、疼痛、熱感の四徴が見られることが重要です。皮膚潰瘍の場合は、感染の四徴の他に、膿があることが重要な指標となります。
- <皮膚細菌感染症の分離菌>
- 表皮ブドウ球菌(皮膚常在菌で病変部に定着している可能性が多い)と黄色ブドウ球菌で全体の7割近く占めます。特に黄色ブドウ球菌が優位です。
- 黄色ブドウ球菌の20〜40%は、MRSAです。皮膚科領域で分離されるMRSAの多くは、過去1年間入院していない、または医学的処置(透析・外科手術・カテーテルなど)を受けたことがない、健常人に生じた市中感染型MRSAです。市中感染型MRSAは、βラクタム系抗菌薬に対しては耐性を示し他の薬剤に対しては感受性を有していることが多いと言われますが、最近アメリカを中心にβラクタム系抗菌薬以外に多剤耐性を示すUSA300型市中感染型MRSAが報告されています。また市中感染型MRSAが人への強い定着能を持ち、流行する能力を獲得し、家庭や職場などで健常人に感染が拡大することが問題視されています。稀に重篤な壊死性筋膜炎をも起こしうる可能性があります。
- 化膿レンサ球菌(A群β溶血性レンサ球菌と同義である)が、10%以下です。経過が急速で、症状が強く、発熱など全身症状を伴う。
- グラム陰性桿菌が、10%前後です。
- <臨床分類>
- (1)膿痂疹:黄色ブドウ球菌(水疱性膿痂疹)あるいは化膿レンサ球菌(痂皮性膿痂疹)による。膿痂疹の関連として、手足水疱性膿皮症、水疱性遠位指端炎(指尖腹部の水疱形成、手足水疱性膿皮症の亜型)、Bockhart膿痂疹、膿痂疹性湿疹があります。
- (2)癤(せつ、単一の毛包を中心とした毛包周囲の急性炎症)、癤腫症(癤が多発したもの)、癰(よう、隣接する複数の毛包を中心とした急性炎症):毛包を中心とした深在性皮膚細菌感染症であり、原因菌は黄色ブドウ球菌であることが多い。
- (3)化膿性汗腺炎:腋窩、外耳、乳輪、肛門近辺などアポクリン汗腺が毛穴に開口する部位に起きる、急性あるいは慢性化する化膿性の病変です。黄色ブドウ球菌や表皮ブドウ球菌が検出されます。前記部位に、痛みのあるしこり、膿瘍ができたり、うみが出たり、これらがしばしば慢性に繰り返すことから、診断は比較的容易です。膿瘍が出来ている場合、局麻下で切開排膿します。
- (4)多発性汗腺膿瘍:エクリン汗管及び汗腺の黄色ブドウ球菌による化膿性炎症です。夏季、乳幼児の頭部、前額部、鼻背、項部、背部、臀部に好発します。
- (5)丹毒:経皮的に侵入したA群β溶血性レンサ球菌が真皮内で増殖し、菌の産生する発赤毒素が経リンパ管性に拡散することにより発症します。潜伏期は2〜5日で、発熱、悪寒、頭痛、倦怠感などとともに境界明瞭な浮腫性紅斑が、顔面、耳介、下腿などに好発します。
- (6)蜂窩織炎:真皮深層〜皮下脂肪組織のびまん性感染症です。丹毒より深部に拡大し、病変部は隆起せず、健常皮膚との境界は不明瞭である。抗菌薬の治療にも関わらず、水疱形成、壊死へ進展、広範な痂皮やびらん形成、真皮・皮下に膿瘍形成、壊死性筋膜炎へ進展する場合などがあり、慎重な経過観察が重要です。
- (7)壊死性筋膜炎:電撃的な経過で強い全身症状とともに皮膚壊死を伴う重症の皮膚軟部組織感染症です。壊死性筋膜炎は、劇症型溶血性レンサ球菌感染症の一つの症状です。急速に水疱、血疱、表皮剥離、紫斑、点状出血、壊死(無痛性、潰瘍化することも)などを生じ、症状の進行は数時間〜数日で、高熱、激烈な関節痛、筋肉痛、悪心、嘔吐、全身倦怠感を伴い、さらに進行すると血圧低下、呼吸困難、肝障害、腎障害、消化器症状、中枢神経症状などを呈します。入院のうえ、早期診断から緊急のデブリードマン、全身管理、大量の抗菌薬を多剤併用するempiric therapy(経験的治療、特に感染症で病原微生物を同定する前に抗菌薬を投与すること)が、生命予後を決定します。最近の死亡率は、25%前後です。
- 細菌毒素関連感染症(8)と(9):化膿レンサ球菌と黄色ブドウ球菌によるが、最近MRSAが増えています。
- (8)toxic shock syndrome:MRSAを含む黄色ブドウ球菌や化膿レンサ球菌が産生する菌体外毒素によってT細胞が活性化され、炎症性サイトカインの爆発的な誘導が起こることによって引き起こされる疾患です。発熱、低血圧、皮膚粘膜症状、下痢が突然出現し、重篤な多臓器障害をきたします。皮膚粘膜症状の特徴は、触るとひりひりした痛みを訴える日焼け様紅斑、全身のびまん性紅斑や粟粒大紅斑が集簇し融合傾向のこともあります。これらの発疹は、約1週間で落屑を生じます。眼球結膜充血、口腔粘膜にびらん、約半数の症例に苺舌が見られます。
- <治療方針 >
- (a)入院設備のない診療所(クリニック)では、直ちに救急対応の可能な病院に連絡し、搬送します。
- (b)全身の皮膚、粘膜をみて感染巣を見つけ、ドレナージ(体内にたまった膿などを体外に排出します)を速やかに行うことです。次には必ず細菌培養を行い、菌の同定、感受性などの情報をいち早く知り、抗菌剤投与を適切に行うことです。
- (c)ショックの処置、免疫グロブリン投与(外毒素に対する中和抗体を含んでいます)、アフェレーシス(外毒素あるいは増加したサイトカインを除去するために、血漿交換、持続血液濾過透析を行います)などを適切に行うことです。
- (9)ブドウ球菌性熱傷様皮膚症候群(SSSSまたは4Sと呼びます):最近原因菌の60〜90%がMRSAとさえ言われています。症状は、特有な顔貎、全身の紅斑(特に頸部、腋窩、鼡径部)、擦過痛です。診療所(クリニック)を受診した患者さんは、病院小児科または皮膚科を紹介し入院の上、全身管理と感受性のある抗菌薬を全身投与します。
- <抗菌薬の選択と投与法>
- ペニシリン・セフェム系抗菌薬は、empiric therapyの第一選択として使用します。
- マクロライド系抗菌薬は、化膿レンサ球菌に感受性が落ちます。
- ペニシリン・セフェム系抗菌薬を投与して3日経っても軽快しない場合は、市中感染型MRSAの可能性が高いので、ホスミシン、テトラサイクリン(9歳以上)、レスピラトリーキノロン(第IIb世代以降のニューキノロン系抗菌薬、16歳以上)、ファロペネム、ST合剤などを試してみるべきです。16歳以下に投与出来るニューキノロン系抗菌薬は、トスフロキサシン(商品名:オゼックス細粒小児用)、ノルフロキサシン(商品名:小児用バクシダール錠50mg、乳児には投与出来ず)です。
- ニューキノロン系抗菌薬は、濃度依存性殺菌作用と長い持続効果により、1日に何回かに分けて投与するより投与回数を減らし、1回の投与量を増やした方が治療効果が高い。
- βラクタム系抗菌薬は、時間依存性殺菌作用と短い持続効果により、1回の投与量を増やすよりは、1日あたりの投与回数を増やした方が治療効果が高い。
- テトラサイクリン系抗菌薬は、歯牙の着色の可能性があるため、8歳以下の小児には投与すべきではありません。
- 帯状疱疹は、水痘・帯状疱疹ウイルス(以下VZVと略します)の再活性によって生じるウイルス感染症です。水痘罹患後、VZVは三叉神経節または脊髄後根神経節の神経細胞などに潜伏感染し、加齢、ストレス、紫外線、寒冷(1月に患者数の増加あり)、免疫低下などの要因によって再活性をきたします。活性化したVZVは神経線維束に沿って走行し、神経支配領域の表皮細胞内で増殖し、皮膚病変として帯状疱疹を生じます。
・疼痛や知覚異常が片側の神経分布に沿って数日~10日程度先行し、紅色丘疹、浮腫性紅斑が出現後、水疱が生じます。水疱から膿疱を経てびらんや潰瘍となり、痂皮形成し治癒します。(治療しない場合4週間位で痂皮形成します)
・水疱が遷延している症例は、ウイルス増殖の持続を意味しています。
・複発性帯状疱疹:2つ以上の神経支配領域に発症します。
・散布疹を有する帯状疱疹:ウイルス血症を起こし、皮疹が24個未満。
・汎発性帯状疱疹:ウイルス血症を併発し全身に水疱が散発します。皮疹が24個以上。
・皮疹の重症化:水疱が大きい、水疱の周りに紅斑がない、血疱がある、神経支配領域を越えて皮疹が広がっている(散布疹、汎発疹)
・基礎疾患のある方は、帯状疱疹が再発することがあります。
・その他の皮膚症状:VZVによる毛嚢炎、VZV後多形紅斑、帯状疱疹後肉芽腫、帯状疱疹後発汗障害など
<帯状疱疹関連痛 ZAP>
・急性期帯状疱疹痛は、侵害受容性疼痛が中心です。
・皮疹治癒後3ヶ月以上持続する帯状疱疹後神経痛(以下PHN)は、神経障害性疼痛と心因性疼痛が強まることによります。
・PHNに移行するハイリスク群は、高齢者、皮疹の重症化、重度の急性期帯状疱疹痛(痛みで眠れない程が目安)があげられます。
<帯状疱疹の合併症>
(1)Ramsay Hunt症候群:耳介の帯状疱疹 、顔面神経麻痺、疼痛や知覚異常以外に耳鳴・難聴・めまい(第8脳神経症状)を伴います。(3主徴全てが揃うのは60%程度)舌や口蓋粘膜に病変が出現する場合があります。Ramsay Hunt症候群の約30%は、顔面神経麻痺が耳介の帯状疱疹に先行して出現し、初期にBell麻痺(特発性片側性末梢性顔面神経麻痺)と診断されてしまいます。Ramsay Hunt症候群には、耳介の帯状疱疹や第8脳神経症状を伴わない無疱疹帯状疱疹が存在し、それらがBell麻痺の約20%を占めて混在していることも明らかになっています。このため、Bell麻痺と診断されても、麻痺が強い、耳痛・後頭部痛が強い、味覚異常・舌のしびれ・耳鳴などの症状がある場合にはRamsay Hunt症候群を疑い治療を開始すべきと考えます。さらに顔面神経麻痺が高度の場合は、1週間以内に耳鼻咽喉科・麻酔科・神経内科などの専門医へ紹介致します。
(2)Hutchinson徴候:鼻尖部及び鼻背部( 三叉神経第1枝領域)の帯状疱疹は、高率に眼症状(結膜炎、角膜炎、虹彩炎など)を伴うと言われています。
(3)眼球運動障害
(4)膀胱直腸障害:帯状疱疹の約0.6%にみられると報告されています。
<診断>
・典型例は、皮膚症状より診断は可能です。
・血清学的にCF法、EIA法によるIgGのペア血清で抗体価の上昇を確認します。
<治療>
- 発症72時間以内に抗ヘルペスウイルス薬を7日間投与します。抗ヘルペスウイルス薬には、アシクロビル(後発医薬品あり)、バラシクロビル塩酸塩(後発医薬品あり)、ファムシクロビル(後発医薬品あり)、2017年9月7日発売されたアメナメビル(商品名アメナリーフ200mg、下記で説明)があります。注意として、抗ヘルペスウイルス薬の内 アシクロビル、バラシクロビル塩酸塩、ファムシクロビルを投与する際に高齢者や腎機能障害患者では、クレアチニンクリアランス値を指標とした用法・用量を調整することが重要です。当院では、堀尾 勝 先生が開発されマルホ製薬が提供するクレアチニンクリアランスカリキュレーターを利用し、腎機能に応じた本剤の減量を実践しています。
- 汎発性帯状疱疹、高齢者の三叉神経領域(特に第1枝)の重症例、帯状疱疹が重症化すると予想される免疫低下のある患者(AIDS、臓器移植、悪性腫瘍など)は、入院し抗ヘルペスウイルス薬の点滴静注が必要な場合があります。
- Ramsay Hunt症候群を来した症例は、麻痺発症5日以内にプレドニゾロン(麻痺スコアにより軽症30mg/日経口、中等症60mg/日経口、重症120mg/日静注)を投与します。
- 急性期帯状疱疹痛に、アセトアミノフェン(最高投与量は1回1000mg、1日4000mgまで)または非ステロイド系抗炎症薬を処方します。
- PHNには、非ステロイド系抗炎症薬は無効で、プレガバリン(商品名リリカ150mg分2 漸増あり)、ワクシニアウイルス接種家兎炎症皮膚抽出液含有製剤(商品名ノイロトロピン錠4単位)を処方しています。他に 三環系抗うつ薬、ガバペンチン(抗てんかん薬)、選択的セロトニン再取り込み阻害剤(SSRI)、アセトアミノフェンとトラマドール=弱オピオイドの合剤(トラムセット配合剤)などが有効です。前記薬物療法が無効なPHN患者には、ペインクリニックで交感神経ブロックをお勧めします。
-
<アメナリーフ>
- アメナリーフの創薬は米国のアステラス製薬で、第Ⅰ相試験で血小板減少症が認められFDAにより開発中止となりました。その後マルホが開発権を取得しアメナリーフとして血小板減少症との関連を調査、治験以前に服用していたイブプロフェンによる血小板減少症と考えられ、アメナリーフによる副作用であるという因果関係が見つからなかったという経緯で、発売に至りました。
- 作用機序:有効成分であるアメナメビルの標的は、ヘルペスウイルス増殖の初期段階に働くヘリカーゼ・プライマーゼ複合体です。アメナメビルはヘリカーゼ・プライマーゼ活性を直接阻害することで、二本鎖DNAの開裂及びRNAプライマーの合成を抑制し、ヘルペスウイルスの増殖を初期段階で阻害します。これは既存の抗ヘルペスウイルス薬とは異なる新規作用機序です。
- ウイルスが増えるのを抑えるお薬です。効果があらわれるまで少し日数がかかることがあります。
- 代謝・排泄:肝臓で代謝され、大腸から排出されます。腎機能による薬物動態への影響が小さく、クレアチニンクリアランスに応じた投与量設定の必要性がありません。
- 服用方法:アメナリーフ200mg1日1回2錠 食後 7日間服用します。
- 相互作用:アメナリーフ錠の有効成分であるアメナメビルは、CYP3A(シトクロムP450という酵素の中の3Aという種類という意味)で代謝され、CYP3A及び2B6活性を誘導することから、薬剤や食品の種類によっては、本剤との相互作用が生じることがあります。
- 併用禁忌:リファンピシン(リファジン 抗結核剤)を投与中の患者さんでは、相互に血中濃度が低下し、本剤及びリファンピシンの作用が減弱するおそれがあります。
- 併用注意する薬剤及び食品
- (1)作用が減弱するおそれがある薬剤:CYP3Aの基質となる薬剤(ミダゾラム 催眠鎮静剤、ブロチゾラム 睡眠導入剤、ニフェジピン 持続性Ca拮抗剤 等)、CYP2B6の基質となる薬剤(エファビレンツ 抗ウイルス化学療法剤 HIV-1感染症に)。
- (2)本剤の血中濃度が上昇するおそれがある薬剤及び食品:CYP3Aを阻害する薬剤(リトナビル 抗ウイルス化学療法剤 HIV感染症に、クラリスロマイシン 等)、グレープフルーツジュース(果実自体を含む)。
- (3)本剤の作用が減弱するおそれがある薬剤:シクロスポリン。
- (4)本剤及びこれらの作用が減弱するおそれがある薬剤及び食品:CYP3Aを誘導する薬剤(リファブチン 抗酸菌症治療薬、カルバマゼピン 向精神作用性てんかん治療剤・躁状態治療剤、フェノバルビタール 催眠・鎮静・抗てんかん剤 等) 、セイヨウオトギリソウ(セント・ジョーンズ・ワート)含有食品。
- 副作用について:承認時までの臨床試験において、14.5%に副作用が認められました。主な副作用は、尿中 β - N ア セ チ ル D グ ル コ サ ミ ニ ダ ー ゼ 増 加 、尿 中 α 1 ミ ク ロ グ ロ ブ リ ン 増 加 、血 中 フィブリン分解産物増加、心電図QT延長でした。臨床検査値異常以外の副作用では、下痢、胃炎、悪心、肝機能異常、薬物過敏症、歯周炎、歯膿瘍、高血圧が認められました。
<臨床成績>
・帯状疱疹の皮疹出現後72時間以内の患者において、治験薬投与開始4日目までに新皮疹形成停止が認められた被験者の割合(新皮疹形成停止率)アメナリーフ81.1%、バラシクロビル塩酸塩75.1%とアメナリーフが優位でした。
・新皮疹形成停止までの日数(両者4日)に有意差なし
・完全痂皮化までの日数(アメナリーフ9日、バラシクロビル塩酸塩8日)に有意差なし
・治癒までの日数(両者11日)に有意差なし
- 当院では、高齢者や腎機能障害患者さんにアメナリーフを処方しています。
- ウイルス性疣贅は、ヒト乳頭腫ウイルス(以下HPVと略します)感染による皮膚・粘膜良性腫瘍の総称で、俗にいぼと呼ばれます。原因HPVの違いにより、以下の臨床病型があります。
- <HPVの特徴>
- 約150種類のHPV型があります。
- 各HPV型と臨床病型は基本的に相関しています。
- 悪性腫瘍を発症する型があります。
- 人から人への直接接触感染と器具などを介した間接接触感染があります。
- 潜伏期間は数週から数年と一定しませんが、通常1~6ヶ月、平均3ヶ月程度とされています。潜伏感染もあります。
- <ウイルス性疣贅の臨床病型>
- (1)尋常性疣贅:HPV2/27/57の感染により、表面乳嘴状丘疹が手指背部、膝、足底(足底疣贅、モザイク疣贅)、顔面・頸(糸状疣贅)などに生じます。
- (2)封入体疣贅:HPV1の感染により幼小児の手掌・足底に単発する中心陥凹性のドーム状丘疹で、痛み・発赤を伴うミルメシア、HPV4/60/65による黒い色素性疣贅、HPV60によるridged wart、そしてHPV63による白色角化性の点状疣贅などがあります。以上を総称してミルメシアと呼ぶことがあります。
- (3)HPV関連表皮様嚢腫:足底部に発症するHPV60や57感染嚢腫の可能性があります。発症病理としてHPV感染によるエクリン汗管の類表皮化生が考えられます。
- (4)扁平疣贅:主としてHPV3/10の感染により、正常皮膚色ないし褐色の多角形扁平丘疹が顔面、前腕部に多発します。ケブネル現象と呼ばれる、線状配列像を伴うことが多いです。また多発する扁平疣贅が一斉に炎症症状を呈する場合、通常その数週間後に自然消退することがあります。
- (5)疣贅状表皮発育異常症(EV):常染色体性劣性遺伝、幼小児期より癜風・扁平疣贅様皮疹を生じ、長じて半数以上に皮膚癌(露光部に)を発症します。HPV5/8/17/20(EV型)が検出されます。EV型が健常人にも普遍的に不顕性感染(毛包が潜伏感染部位)し、免疫抑制状態により顕性化することが考えられています。
- (6)尖圭コンジローマ:HPV6/11の感染により、外陰部や肛囲に鶏冠状の疣贅が多発します。性行為感染症ですが、幼小児の場合産道感染や性的虐待も考えられます。尖圭コンジローマの治療は、薬物療法(以下ベセルナクリーム5%を参照)と外科的療法(当院では液体窒素凍結療法)の2つに分類されます。
- (7)ボーエン様丘疹症:HPV16及びその近縁型(子宮頸癌の原因ウイルスでもあります)の感染により、外陰部や肛囲の皮膚・粘膜に散在あるいは集簇して生じる多発性黒褐色斑ないし丘疹を生じます。ボーエン病様の病理組織所見を呈し、ボーエン病に比べて若年で発症し多発します。自然消退がある一方、悪性化の報告もあります。
- <診断と治療>
- 臨床所見より診断は容易です。鑑別に病理組織検査やウイルス検出法を用いることがあります。(当院では未実施)
- 当院の治療は、液体窒素凍結療法(週1回の保険診療)を中心に、スピール膏貼付、グルタルアルデヒド塗布、活性型ビタミンD3誘導体製剤(保険外適応)塗布または密閉療法、ヨクイニン内服などを補助療法としています。
- <ベセルナクリーム5%>
- 2007年12月10日に保険適用の尖圭コンジローマ治療薬として発売されました。一般名イミキモドは、1997年に米国FDAにより尖圭コンジローマ治療薬として承認されて以来、世界の75以上の国と地域で承認されています。2011年11月25日国内における日光角化症の効能・効果の追加承認を取得しました。以下尖圭コンジローマ治療薬としての内容を記載します。
- イミキモドの薬効薬理作用
- (1)サイトカイン(IFN-αなど)の産生促進。
- (2)細胞性免疫応答の賦活化によるウイルス感染細胞の障害。
- (3)抗ウイルス作用。
- (4)単球あるいは樹状細胞に存在し、種々の病原微生物の構成成分を特異的に認識し、免疫応答の誘導に関わる細胞膜受容体であるトール様受容体(TLR−7)に対するアゴニスト(作動薬)活性。
- 効能・効果:尖圭コンジローマ(外性器又は肛門周囲に限る)
- 用法・用量:疣贅部位に適量を1日1回、週3回(例えば月・水・金、火・木・土曜日)、就寝前に塗布して下さい。塗布後はそのままの状態を保ち、起床後に塗布した薬剤を石鹸を用い、水又は温水で洗い流して下さい。本剤塗布後6~10時間を目安に必ず洗い流して下さい。1回分のぬり薬を使用した後、残ったぬり薬は廃棄し、手指を石鹸で洗って下さい。本剤の使用期間は原則として16週間までとします。重度の炎症反応が局所に現れることがあります。
- 副作用:製造販売後の使用成績調査において、主な副作用は、紅斑 、びらん、表皮剥離等の塗布部位の皮膚障害及び疼痛、刺激感、 痒感等の 塗布部位反応でした。
- 注意:妊婦・産婦・授乳婦等への投与は、治療上の有益性が危険性を上回ると判断される場合にのみ使用して下さい。子供への投与は、安全性が確立していません。
- 臨床成績:尖圭コンジローマ患者を対象とした二重盲検用量反応試験において、ベセルナクリーム5% の疣贅完全消失率は63.6%で基剤群より有意に高かった結果でした。
- 伝染性軟属腫(みずいぼ)は、伝染性軟属腫ウイルスが原因で、下記好発部位に小丘疹として発症し多発します。
- 感染の機会があっても発症までに14〜50日の潜伏期間があります。
- <好発部位>
- 体幹・四肢を中心に、特に腋窩部に多く、顔・首に広がることもあります。
- 水泳をしている児童は、水着被覆部やプールで使用している用具に接触する部位。
- 乾燥部位や掻き壊した湿疹部位。
- <好発年齢>
- 乳幼児・幼稚園児・小学生児童に多く、成人は稀です。
- <感染経路>
- みずいぼのある人から直接接触感染します。
- タオルやビート板などプールでの補助用具を介して、間接接触感染することがあります。
- <みずいぼに感染しやすい方>
- プールで水泳をしている。
- 兄弟姉妹にみずいぼがあり放置している。
- アトピー性皮膚炎があり、皮膚の抵抗力が低下している。
- 全身の抵抗力が低下している。
- <診断>
- ダーモスコピーで小丘疹内の軟属腫小体を確認する。
- みずいぼを疑う小丘疹をつまみ顕微鏡検査で軟属腫小体を確認する。
- <治療>
- 乳幼児から小学生児童は、貼付用局所麻酔剤ペンレス(1回に半分まで貼れます)を治療の1時間半から2時間前に貼って来て頂き、トラコーマ摂子でみずいぼをつまんでとっていきます。(伝染性軟属腫摘除という処置です)
- なおペンレスは、伝染性軟属腫摘除時の疼痛緩和に対し保険適応薬剤のため、使用法を説明し治療の前にお渡ししています。
- <日常生活の注意>
- みずいぼは、小さく少ないうちに放置せずなるべく早く治療しましょう。
- みずいぼのある兄弟姉妹と入浴したり、タオルを一緒に使わないで下さい。
- プールで水泳の後は、よくシャワーを浴び、家で適切な薬を塗って下さい。
- <みずいぼを放置せず治療したほうがいい理由>
- (1)入浴・水泳時に、兄弟姉妹や学童への感染を予防するため。
- (2)みずいぼを放置し増数してしまってから治療するのは、治癒までに多くの治療回数を要し、子供に多大な苦痛を与えるため。
- (3)みずいぼは6〜9ヶ月で自然消退することが多いと言われていますが、個人差があり正確に予想するのは困難で、1年以上に及ぶこともあります。その間に(1)と(2)の心配が常にあるため治療をお勧めしています。
- 単純ヘルペスウイルス(herpes simplex virus 以下HSV)による皮膚・粘膜感染症です。
- HSVにはHSV-1とHSV-2の2種類の型があり、HSV-1は主に口唇や顔面などの上半身に、HSV-2は主に性器などの下半身に再発を繰り返します。
- 初感染の後、病気が治ってもウイルスは体内から消えることなく、知覚神経節の神経細胞に潜伏感染し、再活性化の機会をうかがっています。発熱、日光曝露、疲労、ストレス、月経を契機に、潜伏ウイルスが増殖を再開し、知覚神経を下行して皮膚や粘膜に再発病変(水疱やびらん)を生じます。
- <感染経路>
- 直接接触感染
- タオルや食器などを介して間接接触感染
- 性器ヘルペスは性行為感染症
- ウイルスの無症候性排泄あり
- <臨床病型>
- (1)口唇ヘルペス
- (2)性器ヘルペス
- (3)ヘルペス性歯肉口内炎
- (4)ヘルペス性ひょう疽
- (5)角膜ヘルペス
- (6)カポジ水痘様発疹症:アトピー性皮膚炎など皮膚疾患を発生母地として、HSVが広範囲に拡大する病気です。
- <臨床症状>
- ピリピリとした痛みや違和感と共に皮膚あるいは粘膜に小水疱が集簇性に出現します。粘膜では、水疱は破れ、びらんや浅い潰瘍として見られることが多いです。初感染の場合、局所に強い炎症や発熱などの全身症状を伴うことがあります。再発病巣の場合は、通常7〜10日で痂皮化し治癒します。
- <診断と検査>
- 多くの場合臨床症状で診断出来ます。診断困難時の検査として、Tzanck試験によるウイルス性巨細胞の証明、蛍光抗体法によるHSV抗原の検出、血清抗体価の測定、PCR法によるHSV DNAの検出などがあり、医療機関により出来る検査が実施されます。
- <治療>
- 再発例で軽症の場合やピークを過ぎた症例では、抗ヘルペスウイルス外用薬(アシクロビル、ビダラビン)を塗布します。
- 初感染や中等症の場合は、抗ヘルペスウイルス薬(アシクロビル、バラシクロビル、ファムシクロビル)を内服します。
- カポジ水痘様発疹症、急性型性器ヘルペスなどで全身症状が強い重症例や免疫不全患者に対しては、病院皮膚科で抗ヘルペスウイルス薬の点滴静注を行います。
- 年に6回以上の再発をみる性器ヘルペスに対しては、バラシクロビルを継続的に内服する再発抑制療法があります。バラシクロビル 500mg1錠分1、1年間投与、1年後に投与継続の必要性について検討する。52週間投与し、未再発率は40%。
- 水痘・帯状疱疹ウイルス(varicella zoster virus 以下VZV)の初感染により起こる感染症です。例年冬から春に流行します。
- 感染経路:空気感染、飛沫感染及び接触感染
- 潜伏期間:10〜21日(平均約2週間)
- <臨床症状>
- 紅斑から始まり、丘疹、水疱、膿胞を経過して痂皮化します。新旧の皮疹が混在するのが特徴です。典型例では1週〜10日間程度で皮疹がすべて痂皮化し治癒します。重症例では肺炎、肝炎、中枢神経合併症などを発症し死亡する例もあります。成人発症の場合重症化することがあります。
- 先天性水痘症候群:TORCH症候群の一つです。妊婦が妊娠初期にVZVに感染すると、流産や胎児に四肢低形成、瘢痕性皮膚炎、眼球異常、精神発達遅滞などの新生児に重篤な後遺症を起こすことがあります。
- TORCH症候群とは、胎盤感染により胎児に重篤な奇形や恒久的な臓器・神経・感覚器障害を引き起こす恐れのある疾患病原体の頭文字を取って名付けたものです。
- T:Toxoplasma gondii トキソプラズマ
- O:Others 梅毒トレポネーマ、B型肝炎ウイルス、コクサッキーウイルス、EBウイルス、VZVなどその他多く
- R:Rubella 風疹ウイルス
- C:Cytomagalovirus サイトメガロウイルス
- H:Herpes simplex virus 単純ヘルペスウイルス
- 出産40日前〜出産2日後に妊婦が水痘を発症した場合、新生児は生後5〜10日頃水痘を発症し、抗ウイルス薬による治療が行われないと約30%が死亡します。
- <診断と検査>
- 典型例は、皮疹・経過・水痘患者との接触歴・ワクチン接種歴などから診断は可能です。
- 血清学的診断ではEIA法で急性期と回復期でのIgG抗体価の有意な上昇かIgM抗体を検出すれば診断可能です。
- <治療>
- 発症後早期から、症状の軽減や治癒までの期間の短縮のため、抗ヘルペスウイルス薬を使用します。(1日3回服用)二次感染を併発している場合抗菌薬、発熱にアセトアミノフェン、強い痒みに抗ヒスタミン薬を投与し、皮疹にカチリを塗布します。
- <予防:水痘ワクチン>
- 平成26年10月1日から、水痘ワクチンが定期接種となりました。(実際の接種は小児科でお願いします)水痘ワクチンの1回の接種により重症の水痘をほぼ100%予防でき、2回の接種により軽症の水痘も含めてその発症を予防できると考えられています。水痘ワクチンの定期接種は、生後12月から生後36月に至までの間にある方(1歳の誕生日の前日から3歳の誕生日の前日までの方)を対象としています。2回の接種を行うこととなっており、1回目の接種は標準的には生後12月から生後15月までの間に行います。2回目の接種は、1回目の接種から3月以上経過してから行いますが、標準的には1回目接種後6月から12月まで経過した時期に行うこととなっています。詳細は厚生労働省HPを参照下さい。
- ワクチンウイルスの増殖は接種後5~7日にピークとなり、血液中にインターフェロンが検出されます。ワクチン接種後10日ぐらいからウイルスに特異的な細胞性免疫ができます。また、血中抗体は2週間後から出現し始め6~8週間後に最高値となります。
- 罹患歴や予防接種歴がなくVZVに曝露した場合、曝露後3日以内に緊急ワクチン接種することで発症および重症化予防が可能です。(潜伏期間が約2週間で、ウイルスが血液に入る前にワクチンにより誘導される細胞性免疫が早く生ずるため)
- なお水痘は、学校保健安全法による第二種学校感染症に分類されていて、全ての発疹が痂皮化するまで出席停止となります。外出も控えるほうが望ましいです。
- Gianott-Crosti症候群あるいは小児丘疹性肢端皮膚炎とも呼ばれ、ウイルス感染症の一つです。乳児から成人まで見られますが、1〜6歳までの小児に多い。最近では、B型肝炎ウイルスが原因のGianott病も含めてGianott症候群と診断します。
- <原因となる病原体など>
- (1)A、B、C型肝炎ウイルス:B型肝炎ウイルスによるものは減少
- (2)Epstein-Barrウイルス(EBウイルス):多い
- (3)サイトメガロウイルス
- (4)コクサッキーウイルス
- (5)パルボウイルスB19
- (6)ロタウイルス
- (7)風疹ウイルス
- (8)溶血性レンサ球菌
- (9)三種混合ワクチンやインフルエンザワクチン接種後の発症例の報告あり
- <臨床症状>
- (1)両側頬部、四肢伸側、殿部を中心に播種状に分布する充実性の紅色丘疹。四肢左右対称性に分布。時に紫斑、水疱、膨疹や滲出性紅斑なども見られます。皮疹は、通常3〜7週で自然消退します。
- (2)突然皮疹が生じることが多いが、上気道炎や下痢など前駆症状を伴う場合もあります。
- (3)リンパ節腫脹、稀に肝腫大
- <皮膚糸状菌症(白癬)の分類>
- (1)浅在性白癬:皮膚糸状菌の寄生が角層、毛、爪に留まる。皮膚糸状菌が感染する部位によって、(a)〜(f)に分類されます。
- (a)頭部白癬:頭部浅在性白癬と毛包周囲に強い化膿性炎症を伴ったケルスス禿瘡の2種類に分類します。外用抗真菌薬は頭部白癬を悪化させることがあるので、治療の原則は、経口抗真菌薬の内服です。
- (b)股部白癬:外用抗真菌薬を2週間ほど投与し、痒みなどの自覚症状がなくなれば、治療を中止します。
- (c)体部白癬:上記と同様。
- (d)足白癬:小水疱型(汗疱型)、趾間型、角質増殖型に分類し、足背に生じたものは体部白癬とされている。小水疱型と趾間型は、外用抗真菌薬を約1カ月投与することで改善します。角質増殖型は、経口抗真菌薬の内服が必要で、通常 1〜2 カ月ほどの内服治療で改善します。
- (e)手白癬:手背に生じた場合は、体部白癬に含め、手掌、手指、指間に生じた白癬のみを手白癬と呼んでいます。
- (f)爪白癬:下記した爪白癬(爪水虫)をご覧下さい。
- (2)深在性白癬:皮膚の深部(真皮・皮下脂肪織)や内臓に、皮膚糸状菌が寄生しています。
- 足指・手指の爪が、変色・にごってきた、厚くなってきた、切るとボロボロしてきたら爪水虫を疑って下さい。
- <爪白癬の病型分類と治療>
- (1)遠位側縁部爪甲下爪真菌症 DLSO(distal and laterai subungual onychomycosis)
- 爪の遠位部(先端)あるいは側縁部で、白癬菌が爪甲下面から爪甲に侵入して、爪甲が混濁、肥厚、爪甲下角質増殖してきます。爪白癬の7〜9割がこの型といわれています。軽症から中等症は、外用爪白癬治療剤が有効です。重症例には、内服抗真菌薬が有効と言われています。
- (2)楔(くさび)形の爪真菌症
-

爪ネット 楠 俊雄先生より
- 感染経路はDLSOと同様で、くさび形に混濁します。外用爪白癬治療剤が有効です。
- (3)表在性白色爪真菌症 SWO(superficial white onychomycosis)
-

楠 俊雄先生より
- 爪表面の傷口から白癬菌が侵入して、点状ないし斑状の白濁が見られます。DLSOに比べ、症例数ははるかに少ないです。外用爪白癬治療剤が有効です。
- (4)近位部爪甲下爪真菌症 PSO(proximal subungual onychomycosis)
-

爪ネット 楠 俊雄先生より
- 爪の近位部(付け根)から白癬菌が侵入して、爪が混濁します。足の爪では、極めて稀です。外用爪白癬治療剤は無効で、内服抗真菌薬が有効と言われています。
- (5)全異栄養性爪真菌症 TDO(total dystorophic onychomycosis)
-

楠 俊雄先生より
- DLSO、SWO、PSOが進行し、病変が爪全体へ拡大したものです。外用爪白癬治療剤は無効で、内服抗真菌薬でも難治と言われています。
- 白癬菌が証明され爪白癬と診断されましたら、当院ではまず下記外用爪白癬治療剤で治療を開始します。1年以上治療するも、白癬菌が陰性にならない、新たな爪が伸びないなど治癒に至らない患者さんは、外用薬の変更又は内服抗真菌薬へ移行するか治療法を選択して頂きます。
内服抗真菌薬の治療
(1)テルビナフィン塩酸塩連日投与
(2)イトラコナゾールパルス療法(1週間投与後3週間休薬を3サイクルその後観察期間)
(3)ネイリンカプセル(下記で説明)12週間投与その後爪が生え変わるまで観察期間
- 内服抗真菌薬処方前には、肝機能検査など血液検査が必要です。併用禁忌・注意の薬剤がありますので、現在服用されている薬剤をお伝え下さい。なお血液検査が必要で、重篤な副作用があらわれる可能性のある内服抗真菌薬を希望される患者さんは、ほとんどいないのが現状です。
- 外用爪白癬治療剤の治療のみで改善しない患者さんには、ニッパー式爪切りなどで爪甲下角質増殖部を削りなるべく下層を露出する、また新たな爪を伸ばすために爪母をマッサージするなど補助的な処置が必要です。
- <外用爪白癬治療剤>
- (1)クレナフィン爪外用液10%
- 平成26年9月より、新規トリアゾール系化合物であるエフィナコナゾールを有効成分とする日本初の外用爪白癬治療剤クレナフィン爪外用液10%が発売され、爪白癬に有効な治療法が一つ増えました。1日1回罹患爪全体に塗布します。薬剤ボトルの先端にハケがついており爪面に容易に塗り広げることが可能です。また爪甲での透過性に優れ、爪甲内・爪床で高い抗真菌活性を発揮します。なお52週間塗布した結果、日本人の爪白癬の完全治癒率は28.8%(国際共同試験17.8%)、真菌学的治癒率57.1%(55.2%)、健康領域の新たな爪の伸長6.3mm(5mm)というデータがあります。クレナフィンの使い方を映像で確認下さい。
- (2)ルコナック爪外用液5%
- 平成28年4月25日、爪白癬治療剤 ルコナック爪外用液5%(一般名ルリコナゾール外用液)が発売されました。禁忌は、本剤の成分に対し過敏症の既往歴のある患者です。(外用抗真菌剤ルリコンでアレルギー性接触皮膚炎を起こした方)1日1回罹患爪全体に塗布する。臨床試験結果、塗布開始48週後の爪白癬治癒率は14.9%、爪甲混濁部面積比減少率が著効(75%以上減少)は20.1%でした。主な副作用は投与部位の局所性のもので、皮膚乾燥、接触皮膚炎、爪囲炎、湿疹、皮膚炎・皮膚刺激・乾燥症でした。治療は、爪が生え変わるまでの期間が必要です。
- <注意>
- クレナフィンとルコナックは、爪白癬の原因である白癬菌に作用する薬です。薬により白癬菌が消滅しても、変色した爪を改善するものではなく、新しい健康な爪が生え変わるまで根気よく治療を続けて下さい。(爪が生え変わるには、手で半年、足は1年から1年半かかります)
-
<ネイリンカプセル100mg>
- ネイリンの有効成分ホスラブコナゾールは、主活性成分であるラブコナゾールの溶解性や生体内利用率を向上させたプロドラッグであり、ヒトに投与すると速やかにラブコナゾールに変換されます。ラブコナゾールは、真菌細胞の膜成分であるエルゴステロール生合成を阻害することにより、抗真菌作用を示します。平成30年7月27日ネイリンカプセル100mg 発売、経口薬は約20年ぶりの新薬になります。
- 適応:妊婦、授乳婦、小児には投与出来ません。
- 成分・含量(1カプセル中):ホスラブコナゾール L-リシンエタノール付加物169.1mg(ラブコナゾールとして100mg)
- 効能・効果:<適応菌種>皮膚糸状菌(トリコフィトン属)<適応症>爪白癬
- 用法・用量:通常、成人には1日1回1カプセル(ラブコナゾールとして100mg)を12週間経口投与します。食事に関係なく服用できます。
- 使用上の注意:本剤の投与により肝機能障害があらわれることがあり、下記した副作用の結果も踏まえ、肝機能検査を十分に行う必要があります。
- 相互作用
- (1)ラブコナゾールのCYP3Aに対する阻害作用により、シンバスタチン(HMG-CoA還元酵素阻害剤、高脂血症治療剤)、ミタゾラム(催眠鎮静剤)の代謝が阻害されます。
- (2)本剤とワルファリンを併用すると、ワルファリンの作用が増強することがあります。
- 臨床効果:本剤投与開始後48週(12週間経口投与しその後36週間無治療で観察)の完全治癒率は59.4%、著効率は83.1%、有効率は94.4%でした。なお、完全治癒率は被験爪の爪甲混濁部の消失かつ直接鏡検における皮膚糸状菌が陰性、著効率は爪甲混濁部面積比の減少率が 60%以上、有効率は爪甲混濁部面積比の減少率が30%以上の症例の割合としました。上記したDLSOに投与し完全治癒率は76%、PSOは0%、TDOは30%と2021年報告されました。
- 副作用は23.8%。 主な副作用は、γ-GTP・AST・ALT・ALP増加、腹部不快感でした。
ネイリンをお勧めする患者さん:(1)〜(4)全てを満たし(5)か(6)
(1)成人(妊婦・授乳婦は除く)
(2)現在肝機能障害がなく、かつて内服抗真菌薬で肝機能障害の副作用がない
(3)シンバスタチン、ミタゾラム、ワルファリンを服用していない
(4)採血し定期的に肝機能検査を受けられる
(5)上記した爪白癬の病型分類で、重症の遠位側縁部爪甲下爪真菌症DLSO、全異栄養性爪真菌症 TDO
(6)上記した外用爪白癬治療剤で、治癒に至らない
- 白癬菌(水虫の原因菌)の一つであるトリコフィトン・トンズランス菌(Trichophyton tonsurans)は、感染力が強く、皮膚や毛髪を構成するタンパク質を栄養素として、主に頭・顔面・頚・上半身に寄生します。皮膚同士の直接接触で人から感染したり、床に落ちた皮膚のあか(皮)や毛髪から感染することもあります。
- 本菌は、1960年代のキューバ革命に伴う難民が米国に侵入した結果、米国全土で流行し、1990年代には欧州にも拡大定着しました。日本でも2001年頃から高等学校の柔道部員やレスリング部員の間で、この菌による頭部白癬や体部白癬の集団発生例が報告されるようになりました。おそらく柔道やレスリングなどの海外試合を通じて、この菌が国内に持ち込まれたものと考えられます。
- 最近は、柔道・レスリング・相撲など格闘技選手の感染例から、格闘家の父親から乳児へ、また本人・家族に格闘技の経験のない子供に取っ組み合いなど遊びのなかで感染している症例が報告されています。
- この感染症の特徴は、人好性菌のため痒み・痛みなど症状に乏しいことです。本感染症の病型は、主に頭部白癬・体部白癬の2種類です。潜伏期間は、数日から数週間と考えられます。
- <病型>
- (1)頭部白癬:症状の軽い方が多く、鱗屑(フケ)や痂皮(かさぶた)を生じ、毛髪が抜け落ちます。稀に毛根が破壊されると、毛が生えてこないこともあります。医学的には、脂漏型、Black dot ringworm (BDR)、ケルスス禿瘡のいずれもみられます。なお 症状がなくても、ブラシ検査法(当院では未実施)で陽性となる保菌者(無症候性キャリア)が多くみられることも特徴です。
-

頭部白癬

丸型シャンプーブラシと培地
- (2)体部白癬:露出部である顔・頚部・上半身に、単発あるいは多発する直径1~2cmの鱗屑を伴う淡い環状の紅斑を呈することが多い。痒みなど自覚症状に乏しく、皮膚がカサカサになります。
-

顔面の体部白癬
- <治療>
- (1)頭部白癬:抗真菌成分配合シャンプー(商品名 コラージュフルフルネクストシャンプー)で洗髪を毎日3カ月継続し、イトラコナゾール400mg/日 1週間のパルス療法か塩酸テルビナフィン125mg/日を6週間内服します。なお 処方通り内服した患者さんは、3ヶ月後の検査で菌は陰性化します。
- (2)体部白癬(頭皮のブラシ検査法で陰性):1カ月以上抗真菌剤を外用します。難治例には、内服薬を使用することもあります。
- (3)頭部白癬はないが、頭皮のブラシ検査法で陽性(保菌者):培養集落が2以下の菌数の少ない症例は、抗真菌成分配合シャンプー(商品名 コラージュフルフルネクストシャンプー)で様子をみます。培養集落が3集落以上の症例は、上記内服治療を受けて下さい。
-
培地上の集落
- <予防策>
- (1)練習場・施設、部室や自宅の床やマットを毎日電気掃除機で清掃する。
- (2)練習・試合で使う衣類を洗濯する。
- (3)練習・試合後にシャワー・入浴し、頭・体をシャンプー・石鹸で洗う。
- (4)部員間での帽子・練習着・タオルなどの共用は禁止する。
- (5)保菌者・感染者は、抗真菌成分配合シャンプー(商品名 コラージュフルフルネクストシャンプー)を使用する。
- (6)皮疹の早期発見に努め、疑いがあれば、皮膚科を受診する。
- (7)感染者は、練習と試合を休ませ、しっかり治療を受ける。
- (8)保菌者を調べるブラシ検査法(当院では未実施)を、部員や競技者全員に実施する。
- (9)この病気に対する、指導者への啓発活動を行う。
- 以上の内容は、国立感染症研究所、トンズランス感染症研究会のHPを参考にさせて頂きました。
- カンジダは常在菌として定着しているため、カンジダ症の診断には、直接鏡検にてカンジダと思われる菌要素、ぶどうの房状の出芽型分生子集団や仮性菌糸を証明することが必要です。
- <皮膚カンジダ症の臨床病型>
- (1)通常の皮膚カンジダ症:病変部の乾燥に心掛け,外用抗カンジダ薬を使用すれば2週間位で治癒する。
- (2)角質増殖型の皮膚カンジダ症:イトラコナゾールの内服
- (3)爪カンジダ症:イトラコナゾールの内服
- (4)毛に生じたカンジダ症:イトラコナゾールの内服
- (5)カンジダ性指間びらん症:できるだけ水仕事を減らし、手指の乾燥を心掛ける。外用抗カンジダ薬を使用。
- (6)カンジダ性爪囲炎:できるだけ水仕事を減らし、手指の乾燥を心掛ける。外用抗カンジダ薬を使用。
- (7)口腔内カンジダ症:ミコナゾールゲルの塗布あるいはナイスタチンシロップ液、アムホテリシンB シロップのうがい、あるいは内服を繰り返すと治癒することが多い。基礎疾患を有し再発を繰り返す症例では、イトラコナゾール内用液が推奨されます。
- (8)外陰・腟カンジダ症:イミダゾール系腟錠の挿入が効果的です。
- ウイルス・細菌・リケッチアなどの病原体を持つマダニに刺咬されることにより感染します。マダニは野山・やぶ・草むらや田畑に多く生息し、初夏から秋にかけて盛んに活動します。日本は地域によって温度差が大きいため、各地の環境条件に適応したマダニが日本全国に分布しています。
- マダニは、幼ダニ・若ダニは発育のため、成ダニは産卵のために吸血します。動物の血液はマダニにとって唯一の栄養源です。マダニは、睡液に含まれる酵素で皮膚を溶かしながら、鋏角(きょうかく)と呼ばれる針状の構造物で皮膚を切開し、口下片(こうかへん)と呼ばれる突起物 (針状の歯を持つ)を差し込んで吸血します。口下片の鉤状の歯と鋏角により、マダニが皮膚に固定され、吸血時に唾液とともに分泌されるセメント様物質がマダニを皮膚により強く固定します。
- 通常マダニの体長は2・3mmですが、吸血後は体が大きく膨張し100倍以上の体重になります。
・重症熱性血小板減少症候群:以下SFTSと略します
・ライム病
・日本紅斑熱
・ツツガムシ病:ツツガムシはダニの一種で、幼虫が人や小型齧歯類などに吸着し組織液を吸います
・
・日本紅斑熱とツツガムシ病の鑑別は、発生地域・時期や刺し口の性状(両者焼痂と呼ばれる黒色痂皮を伴うが、ツツガムシ病の方がやや大きい傾向あり)・皮疹より行うが、ペア血清の検査結果が出るまで鑑別が出来ないことがあります。
-

このマダニはSFTSウイルスを保有している個体あり 広島県公式サイトより
-

タカサゴキララマダニはSFTSウイルスを保有している個体あり 国立感染症研究所HPより
-

タカサゴキララマダニの吸血後 国立感染症研究所HPより
-

ツツガムシの幼虫 体長0.2mm 秋田県公式サイトより
<診断と治療>
・野山・やぶ・草むらや田畑への立ち入りの既往を聞きます。
・刺し口を全身くまなく探します。
・発熱、刺し口、体に紅斑(紅い発疹)が見られたら、血液検査(ペア血清)を行います。
・感染症を疑ったら、検査結果を待たずに、早期にテトラサイクリン系抗菌薬で治療を開始します。
<感染しないための対策>
(1)野山・やぶ・草むらや田畑へ立ち入る時は、長袖・長ズボンで首にタオルを巻き、肌の露出をなくします。また大阪で小学生がキャンプに行き川遊びの後に、帰宅時足指にマダニが刺咬と報道あり、注意が必要な症例です。
(2)ディート(子供は12%を使用、30%は5〜8時間有効)やイカリジン(子供にお勧め、15%は6〜8時間有効)を用い、虫除けを行って下さい。虫除け効果は、15%イカリジンと30%ディートは同等です。
(3)ペットのダニ退治と健康管理を行って下さい。体調不良のペットとの過剰な接触を控えて下さい。
(4)弱っている野良猫に触れないで下さい。
・マダニに噛まれたら、自分で無理に引っ張り取ろうとしないで、皮膚科を受診して下さい。当院ではTick Twisterでマダニを除去し、マダニの残存する口器の有無はダーモスコピーで確認しています。

Tick Twister
・マダニに噛まれ1〜2週間以内に発熱、下痢、発疹が出現したら医療機関を受診して下さい。
- 疥癬は、疥癬虫(ヒゼンダニ)が人の皮膚角質層内に寄生して起こる強い掻痒を伴う皮膚感染症です。全身衰弱者や、重篤な基礎疾患を有する人、ステロ イド剤や免疫抑制剤の投与などにより免疫能の低下している人など、またそれらを有する高齢者に発症する、角化型疥癬という病型があります。
<感染経路>
・高齢者のいる病院や施設で、疥癬患者から他の高齢者や医療従事者に感染します
・家族内や同室に寝るなど長時間一緒に過ごすことで感染します
・布団など寝具を介し、間接的に感染します
・一夜をともにする位の長い性的接触で感染します
<臨床症状>
・感染後約1ヵ月の潜伏期間を経て、激しい掻痒を伴い発症します
・臍を中心に腹部、大腿部、上肢などに散発する紅色小丘疹。
・陰部、腋窩に好発する紅色小結節。
・手掌に生じる疥癬トンネル。
・ダーモスコピーで疥癬虫を確認することも出来ます
・顕微鏡検査で疥癬虫・虫卵・卵の抜殻や虫の排泄物を検出すれば、診断は確定します

疥癬虫(ヒゼンダニ)
<治療>
・当院で疥癬と診断された患者さんは、通常 ストロメクトールの服用で治療しています。しかし体重15kg未満の小児、妊婦・授乳婦、そして何らかの理由でストロメクトールが服用出来ない患者さんに対しスミスリンローションをお勧めしています。角化型疥癬の治療は下記を参照下さい。
(1)イベルメクチン(商品名ストロメクトール錠3mg): アベルメクチン類から誘導された半合成経口駆虫薬
・適応:確定診断された患者又はその患者と接触の機会がありかつ疥癬の症状のある患者に使用します。
・適応でない方:体重15kg未満の小児、妊婦または妊娠している可能性のあるご婦人、授乳婦には安全性が確立されていないため原則投与出来ません。
・用法・用量:200μg/kgを空腹時に1回水で服用します。患者体重毎の1回当たりの投与量として、体重15〜24kg 1錠、25〜35kg 2錠、36〜50kg 3錠、51〜65kg 4錠、66〜79kg 5錠、80kg以上 約200μg/kgを服用します。なお1週間後に新たな皮膚症状が認められる場合又は顕微鏡検査で疥癬虫を検出した場合、再度同量投与します。
・注意:治療初期に瘙痒が一過性に増悪することあります。肝機能障害のある患者や高齢者では、必要に応じて肝機能検査を行います。
・臨床効果:通常、2回内服により1カ月前後で治癒します。
・副作用:肝機能障害、黄疸、血小板減少、中毒性表皮壊死融解症、皮膚粘膜眼症候群など。
(2)フェノトリン5%ローション(商品名スミスリンローション5%):成分は合成ピレスロイド
・適応:体重15kg未満の子供、何らかの理由でイベルメクチンが服用出来ない患者。
・使用方法:1週間隔で1回1本(30g)を頸部以下の皮膚に、手・足指の間、陰股部、臀部まで隙間なく塗布します。塗布後約12時間以上経過してから入浴、シャワーなどで洗浄除去します。少なくとも 2 回の塗布を行います。
・注意:小児では体表面積が小さいことから、1 回塗布量を適宜減量します。授乳婦へ投与する場合、少なくとも 1 週間は授乳を中止して下さい。
・副作用:皮膚炎、GOT・ GPT上昇 など。
(3)掻痒が強い場合には、抗ヒスタミン薬の内服、オイラックスクリーム10%の塗布を併用することがあります。オイラックスクリーム10%は、小児においては広範囲の部位には使用しないこと、妊婦においては大量または長期にわたる広範囲の使用は避けて下さい。
(4)角化型疥癬の治療は、外用薬で厚い角質層を除去、(1)または(2)、あるいは(1)と(2)の併用が推奨されています。ただし(1)と(2)の併用は有効性・安全性が未確認です。
<日常生活の注意>
・通常の疥癬の場合は、特別な対策は必要ありません。ただ患者に接触した同室者・家族・医療従事者などに予防的治療が必要なことがあります。
・角化型疥癬の場合、患者の衣類は別に洗濯し乾燥器にかけるか、50分間熱湯処理し一緒に洗濯して下さい。さらにシーツ・寝具などリネン類は、ストロメクトール錠内服の翌日や外用剤処置し洗い流した後に交換して下さい。使い終わった物は、ピレスロイド系殺虫剤で殺虫して下さい。患者がいた居室、布団、患者専用の車椅子・ストレッチャー、患者の立ち回った場所に掃除機をかけるかピレスロイド系殺虫剤を散布して下さい。
・疥癬虫が死滅するまでステロイド外用剤は使用しないで下さい。
・家族にかゆい症状がある時は、必ず受診して下さい。
- 詳細は日本皮膚科学会の疥癬診療ガイドライン(第3版)をご参照下さい。
- <毛虫皮膚炎の分類>
- (1)毒針毛型:ドクガ科の幼虫(毛虫)には数十万本以上の微細な毒針毛(長さ約0.1mm)があります。毒針毛が皮膚に触れ、毒成分が皮膚に注入されると、個人差はありますが、アレルギー反応によって痒み、膨疹、紅斑、紅色丘疹(赤いブツブツ)を生じます。このタイプは、チャドクガ、モンシロドクガ、ドクガ、キドクガなどドクガ科のものと、マツカレハ、ツガカレハなどカレハガ科のものがあります。
- 毛虫は、種によって決まった植物の葉を食害します。例えば、
- チャドクガは、毛虫の時期は5〜6月、8〜9月の年に2回で、公園や人家の庭のツバキ、サザンカの葉を食べます。最も被害が多いです。
- モンシロドクガは、毛虫の時期は5・7・9月で、雑木林や人家周辺のサクラ、ウメ、リンゴ、クリ、クヌギ、クワなどの葉を食べます。
- ドクガは、毛虫の時期は5〜6月で、雑木林や人家周辺のサクラ、ウメ、バラ、イタドリなどの葉を食べます。
- マツカレハは、毛虫の時期は4月頃で、公園や人家の庭のアカマツ、クロマツ、カラマツなどの針葉を食べます。
-

チャドクガの幼虫の集団と成虫

モンシロドクガの幼虫と成虫

ドクガの幼虫と成虫
-

マツカレハの幼虫
- (2)毒棘型:イラガ科の幼虫(毛虫)には鋭い毒棘があり、これに触れると先端部から毒液が注入され、その毒成分の刺激によって激しい痛みが出現し、同時に紅斑、膨疹が見られますが数時間で軽快します。その後、個人差はありますが、毒成分に対するアレルギー反応で紅斑、腫脹が生じる場合があります。このタイプは、イラガ、アオイラガ、ヒロヘリアオイラガなどイラガ科のものがあります。
- 毛虫は、種によって決まった植物の葉を食害します。例えば、
- イラガは、毛虫の時期は7〜9月で、雑木林や人家周辺のカキ、サクラ、ウメなどの葉を食べます。
- ヒロヘリアオイラガは、毛虫の時期は6〜10月で、主に公園や人家周辺のサクラ、バラ、クスノキ、カエデ、カキなどの葉を食べます。
-

イラガの幼虫

ヒロヘリアオイラガの幼虫
- <チャドクガの毛虫皮膚炎>
- チャドクガは、本州、四国、九州では5〜6月、8〜9月の年に2回、卵から孵化して幼虫(毛虫)になり、公園や人家の庭のツバキ、サザンカの葉を食害します。毛虫には数十万本以上の微細な毒針毛があり、毒針毛が皮膚に触れると2・3時間で赤く腫れ痒くなります。2度目以降は、アレルギー反応によって痒みを伴う紅斑と紅色丘疹(赤いブツブツ)が出現します。部位は、首、腕など露出部に出ることが多いですが、シャツの襟や袖から中に入ってしまったり、洗濯物についていたりすると被覆部にも皮疹が出てきます。また成虫の尾端についている毒針毛や樹木に残っている毒針毛によって、発症することがあります。毒針毛が刺さっていれば、ガムテープなどを貼って除去し、水で洗い流して下さい。痒みと炎症症状が強い場合は、皮膚科を受診下さい。抗ヒスタミン薬内服、ベリーストロングランクのステロイド外用薬で治療し、1週間以内には改善します。
- 毛虫の駆除は、専門の駆除業者へ依頼するか、ご自分で駆除する場合は、できるだけ肌を露出しない完全防備で、幼虫が小さく、1枚の葉に群がっている4月、8月頃に幼虫が生息する葉に袋をかぶせ、枝ごと切り取って処分しましょう(駆除については茅ヶ崎市公式サイトより引用)。
- 現在地域では、一年を通し各施設で小規模の発生が見られます。
- 現在の日本では、不潔が原因で寄生していることはほとんどありません。
<アタマジラミを疑ってほしい年齢と所見>
・0〜11 才で、保育園・幼稚園・小学校に通っている子供。
・アタマジラミの卵を有する4割以上の子供が、スイミングスクールに通っていました。
・頭を痒がっている。
・頭髪の中に小さな虫を見つけた。
・髪の毛に産み付けられている卵のようなものを見つけた。
<アタマジラミの見つけ方>
・最も簡単な見つけ方は、毛に産み付けられている卵を探します。
・シラミの卵は、セメント様物質で毛にしっかりと産みつけられているので、引っ掛かる感じがあります。
・ヘアキャストと呼ばれる皮膚分泌物は、指でつまんで引っ張ると簡単に動きます。
・アタマジラミは頭の髪の毛に寄生する昆虫です(皮膚への寄生ではありません)
・卵は、髪の毛に産み付けます(皮膚には産みません)
・卵の色は少し透けた艶のある乳白色です(古くなるにつれ黄褐色に見えます)
・幼虫・成虫、雄・雌ともに吸血します。
・卵は、まとめて産むのではなく、1日に約5~6個ずつ生み続けます。
・温度や湿度にもよりますが、吸血しないと2~3日程度で死んでしまいます。
・成虫は、約 1〜1.5 ヶ月生きます。
<どんなことで寄生する?なぜ子どもに多い?>
(1)髪から髪へ直接感染する例として
・からだを寄せ合って遊ぶ、例えば 子ども達が寄り添って「お絵描きをする・ゲームをする・漫画本などを見る」などでうつることがあります
・保育園などで集団で昼寝する、寄り添って寝る
(2)物を介して感染する例として
・帽子・マフラーなどを共用する・貸し借りする
・子ども同士の遊びでブラッシングする
・各施設の寝具類を介し
(3)髪から髪へ直接及び物を介して感染する例として
・髪が触れるほど混雑した公共交通機関内とそのソファで
(4)洗髪が不十分で増やしてしまうこともあります。
(5)大人にうつる例では、アタマジラミ症の子どもと「添い寝する・抱っこする」などが多い母親や保育園の保母さんなどに見られます。
<アタマジラミの症状>
・痒み:痒みの原因はアレルギー反応です。アタマジラミは吸血する時に唾液を注入します。人にとって異物である唾液中のタンパク質(アレルゲン)が繰り返し注入されることにより、体の中でアレルゲンに反応する IgE 抗体ができてきます。初めての寄生の最初の頃は、抗体が作り出されていないので吸血されても症状がでません。シラミの数がしだいに増え、抗体ができてくるとアレルギーが起きて皮膚症状や痒みが現れます。このため、子どもが盛んに頭を掻きだす頃には、卵がたくさん付いていることがあります。ただし、痒みの程度には個人差があります。
・医学的にお勧めの方法は、スミスリンシャンプー&コンディショナー&梳き櫛を 使う方法です。
(1)頭髪を濡らします。
(2)スミスリンシャンプーを使ってシャンプーします。シャンプー量は、短い髪 10ml〜長い髪 20ml が目安です。
(3)シャンプー後5分間は洗い流さないでください。その後、髪をすすぎます。
(4)コンディショナーを付けて梳き櫛を使って卵を除去します。コンディショナーのすべりを利用して梳き櫛で髪の根元から梳きとります。
(5)髪をすすいで、ドライヤーで乾かし終了。
(6)その後卵の残り具合を点検します。
・以上の方法を 3 日間隔で 4 回(1日目・4日目・7日目・10日目)実施します。
・薬剤を使わない駆除方法として、ベビーオイル&梳き櫛、コンディショナー&梳き櫛、シャンプー&梳き櫛があります。
・

LiceMeister:アタマジラミ用梳き櫛
・以上の内容は、東京都豊島区のアタマジラミ対応マニュアルを参考にさせて頂きました。
<ピレスロイド抵抗性アタマジラミ症について>
・1994年フランスのアタマジラミ症の児童に対し、ピレスロイド系薬剤 0.3%フェノトリンローションの評価を行ったところ、治癒率が40%と著しく低下し、ピレスロイド系抵抗性アタマジラミの存在が明らかになりました。その後、イギリス、イスラエル、米国、オーストラリア、アルゼンチンなどでも確認され、世界的に広がっていることが認識されました。
・日本では、国立感染症研究所における2006年から2011年の5年間の調査で、34都道府県のうち17都道府県で抵抗性遺伝子変異をもつアタマジラミがみつかりました。特に沖縄では96%が抵抗性で、東京都では8.6%、兵庫県7.2%、現在では各地で抵抗性アタマジラミの割合が上昇している可能性が指摘されています。
・沖縄においては、欧米からピレスロイド系抵抗性アタマジラミが早期に侵入し、市販薬が無効であったため、全てのアタマジラミが抵抗性を示すまでに蔓延したと報告されています。
・日本では、ピレスロイド系薬剤の0.4%フェノトリン配合のスミスリンパウダーやシャンプーしか認可されていません。現在沖縄では、可能な限り頭髪を短くし、毎日洗髪しほこりや汗など汚れを落とし、上記した薬剤を使わない駆除方法、コンディショナー&梳き櫛が推奨されています。
- トコジラミはシラミの仲間ではなく、カメムシの仲間で、ナンキンムシ(南京虫)とも呼ばれています。トコジラミは人を好んで吸血し、強い痒みを伴う発疹が出現したり、お店や宿泊施設に経済的被害を起こします。なお生活環境の清潔・不潔に関係なく棲息・繁殖します。
<トコジラミ被害の現状>
(1)一般に市販されているピレスロイド系殺虫剤に1千倍・1万倍抵抗性を持つトコジラミの被害が増加しています。スーパートコジラミと呼ばれています。
(2)世界各地でトコジラミによる被害が増加しています。わが国でも近年急速に被害が増加しており、都市部では一般住宅も含めあらゆる施設で被害がみられます。トコジラミはカバンやバックなど手荷物や、着ている衣服など、人に身近で関係するものに潜んで持込まれることがあります。
(3)トコジラミに対する知識が普及していなく、対策が後手に廻ることがあります。患者さんが持参した虫を、医者に見てもらい、ゴキブリと勘違いした開業医がいるくらいです。
(4)トコジラミ被害が広がる原因として、人や物資の移動とともにトコジラミが運ばれて広げてしまうことがあります。海外からの旅行者などにより持ち込まれている例が多いようですが、都市部では、トコジラミの駆除が進んでいない人たちからの広がりが加わり、多種多様な営業施設にも被害がみられます。発生している営業施設や住居などを利用して、自らトコジラミを自宅に運んでしまうことが確認されています。家具、電気製品・生活用品の移動と共に、図書館などの貸出本などから持ち込んでしまうことがあります。
<トコジラミ刺症の症状>
・トコジラミは、主に夜間や寝ているときに人の手足・首などの露出部を刺して吸血する虫です。
・当院で経験した患者さんは、4月から発症、梅雨から7月に症状が増悪、他院で治療するも治らず来院されました。
・強い痒みを伴う紅斑と丘疹、それらを掻きこわします。吸血後、症状が早くあらわれる方は過去に吸血された経験がある人です。当院で経験した患者さんでは、片側足首より始まり、敷物や畳の縁に接する腕、首・顔、お腹(薄着でお腹が出ていたか)に症状がありました。同室にいる家族にも症状がありました。
・鑑別が必要なダニ刺症は、被覆部である脇の下・お腹・背中に症状が見られます。
・トコジラミはかなり扁平で、狭いすき間に潜むことが可能です。潜み場所の条件がよければ、無吸血でも半年以上も生きることがあります。じっと隠れて吸血相手を待っていることができます。 このため3・4か月以上空き室にしていても被害に遭うことがあります。
・

札幌市公式サイトより

札幌市公式サイトより
(1)成虫の大きさは約5~8㎜、色は褐色~濃褐色、成虫は約1年生きる(温度により異なる) 。
(2)成虫は 1 日に3~6個、一生の間に約200~500 個の卵を産む。
(3)幼虫の大きさは約1~4㎜、色は透けた薄茶色に見える。 幼虫は約1~3 ヵ月かけ5回脱皮して成虫になる (温度により異なる) 。
(4)雄・雌・成虫・幼虫とも刺して吸血する。エサは血液のみ。人や他の動物も吸血するが人を好む。 吸血時間は平均15分~30分弱(論文より) 、夏は概ね4 日~10 日くらいで再び吸血に来る。吸血後は、安全なすき間に隠れている。
(5)虫の生息場所には糞(血糞、乾燥後は小さな黒い点々にみえる)が見られる。糞が多い所には卵・幼虫・成虫もよく見られる。
(6)翅は退化して飛べない。
(7)歩くスピードは幼虫・成虫ともとても速い。
・基本的には、暗く、温かく、狭い場所を好みます。
(1)布団・寝具類やベッド・マットレスの辺縁部、畳と畳の間、畳の下の床板の隙間など
(2)寝室のふすまの四隅、天井・壁・床の隅、柱の接合部やひび割れの隙間、壁紙の剥がれ隙間や裏、じゅうたん、カーペット端下など。室温が高い天井付近の壁のコーナーなどに潜み、 吸血のため天井から落下することもあるそうです。
(3)家具類・電気製品・備品類の下、裏や隙間、 コンセント周りや中、ダンボールの中、カーテン(上部の折り目・縫い目付近に)、張り紙・カレンダー・絵画等の裏
(4)カバンやバックなど手荷物の隙間、本、衣類など
<トコジラミの対策・駆除>
・特に上記生息場所(1)布団・寝具類やベッド・マットレスの辺縁部、畳と畳の間、畳の下の床板の隙間に血糞、卵、幼虫、成虫、脱皮殻があるかよく探します。
・見つけた場合は、
(1)掃除機で吸い取り、吸い取ったゴミは密閉して直ぐ捨てます。トコジラミの数は半減します。
(2)ピレスロイド系殺虫剤は、効かないと思ったほうがいいです。ゴキブリを駆除できる殺虫剤を使用します。(a)と(b)当院で経験した症例は両方使い駆除出来ました。
(a)有効成分 プロポクスル(カルバーメート系):ライオン株式会社 バルサンまちぶせスプレー。
(b)有効成分 メトキサジアゾン(オキサジアゾール系):アース製薬 医薬品トコジラミゴキブリアース。ピレスロイド系とマイクロパウダー配合スプレー、専用アンテナノズルを採用。使用量の目安は1平方メートルあたり45~60秒程度(幅10cm、長さ1mの塗布面に4.5~6秒程度)
<トコジラミ刺症の治療>
・上記の対策と駆除をしながら
(1)痒みが強い場合は、抗ヒスタミン薬を服用します。
(2)ベリーストロングランクのステロイド外用薬が有効です。
・以上の内容は、豊島区池袋保健所生活衛生課作成のトコジラミ ナンキンムシの知識 2016年を参考にさせて頂きました。























































